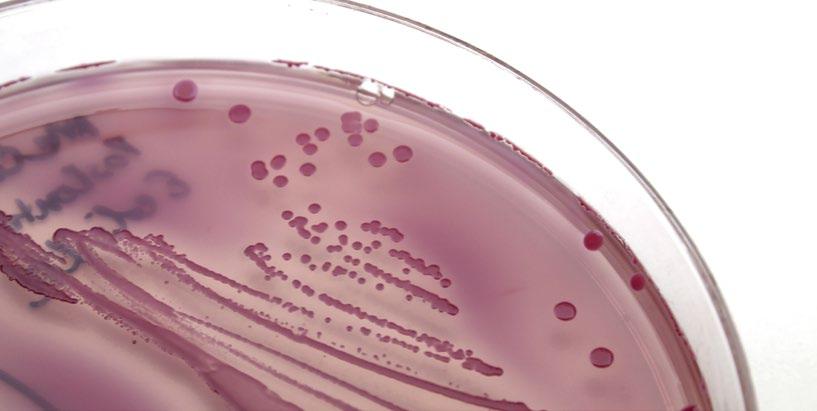

EDICIÓN ESPECIAL
LPN CONGRESS 2025
SEPTIEMBRE 2025

![]()
EDICIÓN ESPECIAL
LPN CONGRESS 2025
SEPTIEMBRE 2025

PILAR DE LA CALIDAD EN LA INDUSTRIA AVÍCOLA
p. 68 Hans Mann
Solución de datos segura basada en la nube

Conecte su planta de incubación con el mundo de los macrodatos
El software de incubación inteligente que convierte los datos en el máximo rendimiento avícola
Las plantas de incubación tienen una gran cantidad de datos valiosos. Desbloquear el potencial de esos datos es una gran oportunidad para mejorar el rendimiento general de las plantas de incubación y de toda la cadena de valor. Con Eagle Trax™, Petersime ofrece el primer software de incubación inteligente que convierte los datos en el máximo rendimiento avícola. Eagle Trax™ le permite digitalizar, analizar y utilizar de manera óptima los datos para incrementar cada vez más la eficiencia, la productividad y la calidad de los pollitos de la planta de incubación.
Con Eagle Trax™, su planta de incubación siempre maximizará el potencial genético de cada huevo fértil y ofrecerá una producción predecible y más rentable de los pollitos de un día para todos los implicados en la cadena de valor avícola.
Escanee para obtener más información:






Niveles de bioseguridad en avicultura: Aplicación externa, interna y del personal
MVZ. José Alejandro Jiménez
Ramírez y MVZ. Cesar Isaac
Ascencio Pérez Tepatitlán de Morelos , Jalisco, México
La importancia de mantener densidades de aves uniformes?
Michael Czaricky y Brian Fairchild Department of Poultry Science - UGA

Aeropuertos: Experiencias didácticas que ayudan a visualizar la reducción de los decomisos y desperdicios durante la prefaena
Eduardo Cervantes López
Consultoría Internacional - Gerencia Productiva e Innovadora en Procesamiento de Aves

La inteligencia artificial y la tecnología de visión transforman el procesamiento avícola
Equipo Técnico BAADER

Causas de infertilidad en gallinas reproductoras
Dra. Priscila Esther Witrado Hurtado
Facultad de Medicina Veterinaria y Zootecnia de la Universidad Nacional Autónoma de México (UNAM)
Cómo 22 años de genómica están moldeando el futuro de la avicultura
Grant Mason Geneticista de Aviagen
Implicaciones y resultados del proceso de incubación sobre la calidad de los pollitos
Vinicius Santos Moura Doctorado en el departamento de Zootecnia de la Universidad Federal de Grande Dourados




Obtén más huevos vendibles, más masa de huevos y más vida productiva

Factores que afectan la calidad del pollito. Parte I
Equipo Técnico H&N
Cascarón del Huevo: Pilar de la calidad en la industria avícola moderna
Hans Mann
Ingeniero Agronomo Zootecista
Instituto Tecnológico y de Estudios
Superiores de Monterrey


Efecto del Di Heptarine® sobre la respuesta inmune a los programas de vacunación en aves de larga vida
M.V. Bruno Vecchi y Vet. Cecilia Rodríguez
Equipo técnico de Vetanco México

Resistencia a los antimicrobianos en la cadena alimentaria avícola y nuevas estrategias para el control bacteriano

Edgar O. Oviedo Rondon
North Carolina State University



Importancia en la avicultura familiar y de traspatio de la Enfermedad de Marek y la Leucosis Linfoide - Parte II
Dra. Norma Calderón y Dr. Leopoldo Paasch
Facultad de Medicina Veterinaria y Zootecnia, UNAM
Reforzando el sistema inmune de nuestras aves

Mireya López
Coordinadora técnico comercial de avicultura en Trouw Nutrition Sur y Centroamérica

Coriza Infecciosa Aviar: Una amenaza controlable
Sergio Álvarez Jiménez MVZ EPA
Equipo Técnico Sanfer
B-Act® Probiótico a base de Bacillus licheniformis que previene el impacto negativo de Clostridium perfringens
Carlos J. Cuello O. Equipo Técnico de Huvepharma
Cobb-Vantress anuncia a Carlos Solorzano como Gerente de Servicio Técnico para América Central
Equipo Técnico Cobb
Grupo Disatyr: 40 años al servicio de la Industria Alimentaria Centroamericana
Equipo Técnico Disatyr
Raíces en la tierra, visión en el futuro: La revolución sostenible de Nutrihuevos
Entrevista con Gustavo Koo
Equipo aviNews Latam

No se pierda la cuarta edición del evento más esperado del sector avícola y de nutrición animal en América Latina: LPN Congress & Expo 2025. Luego de tres exitosas ediciones, este congreso se ha consolidado como el punto de encuentro esencial para los profesionales del sector. Este 2025, vuelve a Miami, reuniendo a expertos, empresas líderes y productores de todo el continente para compartir conocimientos, descubrir innovaciones y debatir los temas que están redefiniendo la industria.
En un año clave para el futuro de la avicultura, LPN Congress es el espacio ideal para encontrar soluciones prácticas y construir redes que impulsen el crecimiento del sector.
La industria avícola latinoamericana enfrenta en 2025 una serie de desafíos complejos y dinámicos. Las tensiones geopolíticas a nivel mundial, los brotes de enfermedades como la Influenza aviar, el impulso hacia la sostenibilidad y el cambio en las preferencias del consumidor están transformando profundamente la forma de producir, comercializar y competir en los mercados locales e internacionales.
Uno de los principales factores que impactan al sector es el entorno geopolítico internacional. Las restricciones comerciales, los aranceles y la volatilidad en el acceso a insumos como granos, aditivos y tecnología generan incertidumbre. Esto obliga a los productores a buscar soluciones que fortalezcan su autosuficiencia y mejoren la eficiencia en sus procesos productivos.

Dr. Miguel A. Márquez DVM, MSc, PhD, Diplomate ACPV. Patólogo Aviar FMVZ / UNAM
La Influenza Aviar, por su parte, sigue siendo una amenaza latente. Su propagación afecta no solo la producción, sino también la exportación, debido a los estrictos controles sanitarios de muchos mercados. Ante esta realidad, la bioseguridad en las granjas se ha vuelto una prioridad, con inversiones crecientes en sistemas de prevención, monitoreo y control de enfermedades.
Simultáneamente, el consumo de productos avícolas combina sabores internacionales y un fuerte enfoque en la sostenibilidad. Los consumidores buscan opciones más creativas, nutritivas y responsables, lo que impulsa la innovación en toda la cadena, desde la alimentación hasta el producto final.
Además, el compromiso con la sostenibilidad ambiental y el bienestar animal ya no es opcional. Las prácticas éticas de crianza, el uso racional de recursos naturales y la transparencia en la cadena de producción son factores clave para mantener la confianza del consumidor y acceder a mercados más exigentes.
Para mantener la eficiencia y rentabilidad, la industria debe enfocarse en una gestión óptima de los granos, mejorar la formulación de los alimentos, fortalecer la genética aviar y optimizar el manejo en cada etapa del proceso productivo.
En conclusión, 2025 representa una oportunidad de transformación para la avicultura latinoamericana. Participar en LPN Congress & Expo 2025 será clave para quienes deseen entender los cambios, anticiparse a los desafíos y liderar el futuro de una industria que alimenta al continente.
EDITOR
GRUPO DE COMUNICACIÓN AGRINEWS S.L.
PUBLICIDAD
Diego Carrasco +34 635 45 82 93 sales@grupoagrinews.com
Karla Bordin +55 (19) 98177-2521 mktbr@grupoagrinews.com
Luis Carrasco +34 605 09 05 13 lc@agrinews.es
Nicole Carletti +57 312 391 9330 avinewslatam@grupoagrinews.com
ATENCIÓN AL CLIENTE Mercé Soler
REDACCIÓN
José Luis Valls
Daniela Morales
Maria de los Angeles Gutiérrez Nicole Carletti
DIRECCIÓN TÉCNICA
Dr. Miguel A. Márquez, DVM, MSc, PhD, Diplomate ACPV Patólogo Aviar/Avian Pathologist FMVZ/UNAM
Ing. Eduardo Cervantes
Consultor internacional de procesamiento avícola
Dr. Guillermo Díaz Arango
Consultor técnico internacional en gallinas de postura
COLABORADORES
Mário Penz Jr. Winfridus Bakker
Juan Carlos López
Mike Czarick Brian Fairchild
info@grupoagrinews.com avinews.com
Revista de distribución gratuita DIRIGIDA A VETERINARIOS Y TÉCNICOS
Depósito Legal Avinews B11597-2013
ISSN (Revista impresa) 2696-8223
ISSN (Revista digital) 2696-8231
Precio de suscripción anual: 90 USD




El término proviene de la unión de “vida” y “seguridad” y, en el contexto avícola, se traduce en acciones sistemáticas aplicadas durante todo el ciclo productivo, sin interrupciones, adaptadas a las condiciones de cada región y tipo de producción (pollos de engorda, postura, reproductoras, etc.).
Existen múltiples guías y manuales que detallan estos procedimientos, todos con el objetivo común de minimizar riesgos sanitarios y garantizar la sanidad del producto final.
Gracias a la implementación adecuada de la bioseguridad, ha sido posible controlar y erradicar diversas enfermedades aviares, lo que ha favorecido el acceso a nuevos mercados nacionales e internacionales. Cuadro 1.-
Los principales agentes causantes de enfermedades en aves —virus, bacterias, hongos, parásitos internos y externos— se encuentran clasificados en el Cuadro 1.
Finalmente, para lograr una protección integral, la bioseguridad debe aplicarse en tres niveles fundamentales: externa, interna y del personal, actuando de forma conjunta para reducir al mínimo los riesgos sanitarios.
A continuación, se describen brevemente estos tres aspectos clave a implementar en una granja:
1. Bioseguridad externa en las granjas avícolas
2. Bioseguridad interna en las casetas
3. Bioseguridad del personal en las granjas avícolas
Enfermedad de Newscastle (Paramyxoviridae)
Influenza aviar (Orthomyxoviridae)
Bronquitis infecciosa (Gammacoronavirus)
Viruela aviar (Poxviridae)
Gumboro (Avibirnavirus)
Enfermedad de Marek (Gallid herpesvirus 2 (GaHV-2)
Laringotraqueítis (Herpesviridae)
Coriza (Avibacterium)
Salmonelosis (Salmonella pullorum, S. gallinarum)
Colibacilosis (Escherichia coli)
Aspergilosis (Aspergillus spp.)
Micotoxicosis (Aspergillus, Fusarium y Penicillium)
Candidiasis (Candida albicans)
Coccidiosis (Eimeria spp.)
Protozoos (Giardia spp.)
Nematodos (Ascaridia galli)
Nematelmintos (Heterakis gallinarum)
Capilarasis (Capillaria, oxiuros)
Taenias (Hymenolepis spp. y Railletina spp.)
Ácaro rojo (Dermanyssus gallinae)
Sarna de las patas (Knemidocoptes mutans)
Garrapatas (Argas persicus)
Piojo de la cabeza (Cuclotogaster heterographa)
Piojo de las alas (Lipeurus caponis; Menopon gallinae)
Piojo del cuerpo (Menacanthus stramineus)
Uno de los aspectos relevantes al iniciar instalaciones de aprovechamiento avícola es la ubicación de estas; de preferencia deben encontrarse retiradas de las áreas urbanas, así como de otras explotaciones de aves o sistemas productivos animales de otras especies, resaltando aquellas granjas de producción porcícola.
Otro aspecto por tomar en cuenta es la orientación de las casetas, debido a que, en climas cálidos, la orientación

Esto también disminuye la propagación de microorganismos entre granjas y casetas a través del viento, vectores o personal.
Además, los materiales utilizados en la construcción de las instalaciones deben facilitar la limpieza, lavado y desinfección, permitiendo que estos procesos se realicen de forma eficiente y rápida
Estas áreas deben contar con zonas de aseo, limpieza y desinfección, reforzando así la bioseguridad interna en la granja.
Las áreas de desinfección deben garantizar la correcta aplicación de detergentes y desinfectantes en vehículos y personas que ingresan a la granja, incluyendo proveedores de servicios externos (albañiles, gas, alimento, electricistas, mecánicos) y personal propio.


Se ha documentado que estas áreas mal gestionadas atraen animales y aves silvestres, lo que puede ser un detonante de brotes de enfermedades que afecten no solo a la granja, sino a toda una región o país.

La protección de las casetas frente al ambiente externo es fundamental para evitar la entrada de aves silvestres, insectos, roedores u otra fauna local que puede ingresar buscando alimento, agua o refugio, y que a su vez puede portar microorganismos dañinos para las aves en producción.

Dentro de esta infraestructura, los techos del galpón deben ser de materiales que aíslen el calor y la radiación solar.
En los costados se requiere instalar mallas pajareras (plásticas o metálicas) cuya función es impedir el ingreso de aves al interior.
Durante ciertas épocas del año, se usan cortinas rompe vientos, generalmente de lona plástica, para bloquear la luz solar, el viento y la lluvia.

En el interior, se debe mantener un microambiente adecuado, controlando factores como iluminación, ventilación, temperatura y humedad, especialmente en casetas cerradas con ambiente controlado.
Estos sistemas garantizan un entorno confortable para las aves, permitiéndoles expresar su potencial productivo y mejorar su bienestar.
Al final del ciclo productivo, es imprescindible realizar la limpieza y desinfección de las casetas.
Se debe remover el material orgánico acumulado, retirarlo completamente y aplicar un período de vacío sanitario.
Durante este tiempo, se lleva a cabo una limpieza mecánica, seguida de un lavado con detergente y una desinfección profunda de cada zona.
Es clave que el personal esté capacitado en el manejo correcto de los productos utilizados, tanto para asegurar la eliminación de microorganismos como para proteger su propia salud.



BACTERICIDA
FUNGICIDA
ESPORICIDA
COCCIDICIDA
· Eficacia probada por normas UNE oficiales europeas.
· 100% Estable.
· 100% Biodegradable.














Habiendo abordado los riesgos en las áreas externas e internas, es momento de hablar sobre la producción y manejo de las aves.
Lo ideal es aplicar el sistema “todo dentro/todo fuera”, donde las aves entran y salen al mismo tiempo.
Este modelo permite vaciar, limpiar y desinfectar toda la granja en una sola etapa, lo que reduce riesgos sanitarios.
Aunque hay granjas que manejan aves de distintas edades (multiedades), esto no se recomienda, ya que puede favorecer la recirculación de patógenos, especialmente en aves jóvenes más vulnerables.
La vacunación también es una práctica esencial en la avicultura para proteger a las aves de enfermedades prevalentes en la zona.
Implementar esquemas de vacunación adecuados es una actividad clave de bioseguridad que toda granja debe aplicar antes de que los patógenos causen pérdidas en la producción o en los inventarios, por su alta transmisibilidad y letalidad.
Asimismo, garantizar el suministro de agua y alimento de buena calidad, retirar y registrar las mortalidades diarias, permite monitorear parámetros importantes para la salud del lote.
Si se identifica una enfermedad de notificación obligatoria, debe informarse de inmediato a las autoridades sanitarias.
En estos casos, pueden ser necesarias medidas como el vaciamiento total de casetas, desinfección intensiva, sacrificio poblacional y manejo adecuado de las aves muertas.
Además, es crucial revisar y fortalecer las medidas de bioseguridad ya establecidas para prevenir futuras incidencias.
Un componente importante dentro de toda explotación avícola para el buen funcionamiento indudablemente es:
El personal humano interno contratado para las diferentes actividades dentro y fuera de la granja y;

Que la capacitación en aspectos de bioseguridad en ellos fortalece su buen desempeño y garantiza a la vez que con el tiempo se adquieran buenas prácticas y hábitos en la granja.
En el caso del personal humano externo (aquel que realiza reparaciones de las casetas, entrega el alimento o insumos para el funcionamiento de la granja, el mismo médico veterinario y propietarios), todos deberán apegarse a las reglas de bioseguridad ya aplicadas para poder acceder con seguridad al interior de la granja.
Toda persona interna o externa debe pasar por las áreas de limpieza, lavado y desinfección” y utilizar ropa exclusiva de la granja.
Además de utilizar ropa propia de la granja, debe permanecer con ella todo el tiempo que se encuentre dentro de la misma.

Los registros de visita o ingreso son importantes, ya que permiten llevar un control detallado de quién entra y sale de la granja, así como el día y la hora.
Esto es crucial para mejorar la seguridad, optimizar la gestión de recursos y ofrecer una mejor experiencia a los visitantes.

El tener un área específica para la desinfección de instrumentos y herramientas utilizados en la granja es un punto sustancial que debe ser parte de la capacitación del personal para que este equipo sea limpiado, lavado y desinfectado constantemente.
Esto debe de realizarse cada vez que se entre o salga de una caseta.
En el mundo, existen varias regiones que concentran una alta densidad de los galpones avícolas, lo que complica y compromete la bioseguridad instaurada en las granjas.
Dado que en muchos casos, la bioseguridad llega a ser precaria o nula, aumentando la presión sobre aquellas unidades productivas que sí la tienen implementada.
Además, en caso de algún incidente zoosanitario, poder hacer la retrospectiva epidemiológica de cuándo, dónde o quién pudo haber ingresado el agente infeccioso en las parvadas o granja.
La bioseguridad en granjas avícolas es fundamental para reducir el riesgo de introducción y propagación de patógenos, prevenir enfermedades, mejorar la salud de las aves y garantizar la sostenibilidad económica del sector.
Esto acarrea problemas como:
Mayor incidencia de enfermedades en la zona.
Aumento del estrés y alteraciones en el comportamiento de las aves.
Gran competencia por recursos como agua y alimento.
Bajos rendimientos productivos.
Aumento en los porcentajes de mortalidad.
Dificultades para conservar el medioambiente en óptimas condiciones, por mencionar los más importantes.
Niveles de bioseguridad en avicultura: Aplicación externa, interna y del personal DESCÁRGALO EN PDF

Nos vemos en Booth B14
Finalmente, cada uno de los puntos señalados debe contar con bitácoras y/o registros, para valorar el correcto funcionamiento de los diversos aspectos descritos;
y, de manera adicional, contar con un plan correctivo diseñado para evaluar, abordar y subsanar los problemas o deficiencias identificadas durante la operación de estos procesos, productos o de cada sistema operativo de la granja.
Estos planes son cruciales para mantener la calidad, el cumplimiento normativo y evitar la recurrencia de errores en los procedimientos ya implementados.




Michael Czarick1 y Brian Fairchild2
1UGA Extension Engineer
2UGA Extension Poultry Scientist

Utilizar el término “promedio” de cualquier cosa puede ser un concepto potencialmente peligroso cuando se trata de aves en crecimiento.
Por ejemplo, en ventilación túnel en pollos de engorde en edad de mercado, la temperatura promedio del galpón puede ser de 26,7ºC, lo que no es necesariamente un problema, pero oculta el hecho de que podría ser de 21,1ºC en el extremo donde entra el aire y de 32,2ºC en el extremo de los ventiladores del galpón, lo que definitivamente sería peligroso.
Durante el clima frío, una humedad relativa diaria promedio del 60% parece ideal, pero en realidad la HR podría ser del 40% durante el día y del 80% por la noche, lo que podría generar una mayor probabilidad de problemas respiratorios.
Por último, pero no menos importante, aunque nuestras aves pueden haber sido colocadas en una densidad relativamente baja, no significa necesariamente que todas las aves tengan la misma cantidad de espacio para comer, beber y moverse.



Temperatura máxima en superficies : 40,6 ºC

. Imagen térmica de aves apiñadas en la zona del panel evaporativo por donde entra el aire en la ventilación túnel.



Temperatura máxima en superficies : 39,2 ºC
en la zona de los ventiladores

Tome el control total del galpón avícola con CATALYST®
Whole House Control de Chore-Time y la aplicación
El control integral CATALYST® le brinda control total de su galpón al alcance de su mano a través de la aplicación móvil CHORE-TRONICS® y el sistema de alertas BROADCASTER™. Los informes en tiempo real y la nueva y elegante interfaz lo mantienen al tanto de su operación.
Tome el control con:
• Una interfaz más fácil de usar con modo oscuro y nuevos íconos.
• Informes en tiempo real a través de la aplicación móvil.
• Actualizatión remota de software y servidores.



• Control de velocidad variable para todo el galpón.
Obtenga más información en www.choretime.com/es/catalystcontrol
Mantener una densidad uniforme de un extremo al otro del galpón es de suma importancia porque afecta el rendimiento de las aves de varias maneras.
Las variaciones en la densidad de aves dentro de un galpón no solo resultan en diferencias en la disponibilidad de espacio para comederos y bebederos, sino también en la cantidad de esfuerzo que requiere un ave para llegar al alimento y/o al agua.
Si hay una cantidad excesiva de aves en una zona del galpón, la humedad de la cama será mayor simplemente debido a que se agrega más heces húmedas a la cama en esa zona.
Además, cuanto mayor sea la densidad de aves, menor será la cantidad de movimiento de aire que habrá sobre la cama, lo que dará como resultado:
Menor secado de la cama.
Aumento en la producción de amoníaco. Problemas en las almohadillas de las patas.
La calidad general del aire también tiende a cambiar en un galpón con variaciones en la densidad.
Cuando el galpón se está ventilando las trampillas de entrada de aire laterales, el aire entra de manera uniforme a lo largo del galpón.


Pero si hay más aves en una zona que en otra, recibirán menos aire fresco por ave que las aves en un área del galpón con menor densidad, lo que da como resultado aire viciado en las áreas de alta densidad de aves, y aire muy fresco en las áreas de baja densidad de aves del galpón.
Los costos de calefacción pueden verse afectados por las diferencias en la densidad de aves.
Durante el clima frío, utilizamos a las aves para calentar nuestros galpones.
Si las aves no están distribuidas de manera uniforme, nuestros pequeños calentadores no estarán distribuidos de manera uniforme, lo que a su vez resulta en diferencias en las temperaturas del aire a lo largo del galpón.
Podemos terminar con ventiladores encendiéndose en un extremo del galpón para enfriar a las aves y la calefacción encendiéndose en el otro extremo para tratar de evitar que las aves se enfríen.
En los galpones con ventilación por túnel, las aves tienden a estar más densas en el extremo donde están los paneles evaporativos de entrada de aire que en el extremo donde están los ventiladores por varias razones:
En primer lugar, la mayoría de las aves se crían tradicionalmente en la zona de los paneles evaporativos y deben trasladarse al extremo de los ventiladores.
Hacer que las aves jóvenes se muevan casi cien metros es difícil, lo que naturalmente lleva a que más aves permanezcan en el extremo del galpón donde se crían en lugar del extremo de los ventiladores sin cría.
En segundo lugar, las aves tienden a migrar naturalmente contra el viento, lo que hace que se desplacen hacia el extremo del galpón donde están los paneles evaporativos si no se instalan y gestionan adecuadamente las vallas antimigratorias.

Por último, pero más importante, la mala distribución de las aves puede resultar muy costosa durante el clima cálido.
Cuanto mayor sea la densidad de aves, menos espacio habrá entre ellas.
Esto hará que las aves sientan más calor y consuman menos alimento y ganen menos peso.
Por último, pero no menos importante, las altas intensidades de luz que suelen producir los ventiladores de túnel, así como el ruido que provocan las lamas de los cierres de los ventiladores cuando cierran de golpe, pueden hacer que las aves se alejen de los ventiladores y se dirijan hacia el extremo opuesto del galpón.

Para ayudar a garantizar que las aves se distribuyan uniformemente por todo el galpón después de haber hecho un inicio de crianza en el criadero,
es importante que las aves migren activamente desde el extremo de crianza al extremo sin crianza y que se instalen vallas antimigración a los pocos días de permitir el acceso de las aves a todo el galpón.
Cuanto más se demore el proceso, más difícil será mover las aves del extremo de crianza al extremo sin crianza del galpón.
Es importante tener en cuenta que las diferencias en la densidad de aves entre los extremos del galpón a menudo no afectarán al aumento de peso de los pollos de engorde hasta la última o penúltima semana de la crianza.
Al principio de la crianza, una diferencia del 20% en la densidad puede no afectar el rendimiento general de las aves,
porque las aves son pequeñas y todavía hay mucho espacio alrededor de los comederos y bebederos y si un área está un poco abarrotada, pueden desplazarse fácilmente por todo el ancho del galpón para encontrar un acceso más fácil al alimento y al agua
Tener un mínimo de dos medidores de agua (áreas de crianza/no crianza), idealmente cuatro en los galpones más largos de la actualidad, es crucial para monitorizar las aves y controlar la distribución de la densidad.
Si el uso de agua no es el mismo en los dos extremos del galpón, la densidad de aves no es uniforme.
Una diferencia del 20% en el uso de agua equivale a una diferencia del 20%
















• Panel de plástico con alta eficiencia de enfriamiento
• Disponible en el rango de altura 1200, 1500, 1800 y 2000mm y espesor 150mm
• Diseño único de canales de aire para mejorar la eficiencia y reducir las pérdidas de presión
• Diseño anti derrame de agua
• Propiedades de oscurecimiento (hasta 1M de lux de reducción)
• No requiere suministro adicional de agua
• Diseñado y producido en Italia




Eduardo Cervantes López
Consultoría Internacional - Gerencia Productiva e Innovadora en Procesamiento de Aves

Inspirado en la precisión de los aeropuertos, se plantea una visión innovadora para optimizar la prefaena avícola, promoviendo el bienestar animal, la reducción de pérdidas y una gestión más eficiente desde la granja hasta el transporte a la planta de faenamiento.

Siempre me ha llamado la atención la gran sincronización existente en los aeropuertos donde se deben monitorear en tiempo real una inmensa cantidad de actividades que deben cumplirse disciplinadamente antes de llegar a estas gigantescas instalaciones. Estando en ellas, al momento de entregar el equipaje, en las salas de espera donde uno debe estar una hora antes de abordar el avión para que, si las condiciones meteorológicas son las adecuadas, la aeronave se retire del túnel de ingreso a la hora programada y el vuelo salga según itinerario.
Lo sorprendente es que cada vez los pasajeros toman mayor conciencia de su responsabilidad dando cabal cumplimiento a lo establecido en cada etapa, porque no quieren correr el riesgo de perder el vuelo.
Estas experiencias me impulsaron a reflexionar cómo aplicarlas durante la prefaena, donde se inicia una cascada de afectaciones en la calidad, el rendimiento y los gastos de operación de los pollos que se recolectan y despachan a las plantas de faenamiento diariamente.
Pongo a consideración de los lectores estas conclusiones:

COMPARACIÓN ENTRE AEROPUERTO Y GRANJA AVÍCOLA
Un aeropuerto se puede asemejar a una granja. Los aeropuertos tienen varios terminales que se homologan a los galpones.

Imagen 1. Terminales
Las salas de abordaje se parecen a los cerramientos que tienen los galpones en muchas granjas. En ellas los pasajeros se encuentran cómodamente sentados y tranquilos – o de pie cuando todas las sillas están ocupadas –, esperando la llamada para iniciar el abordaje. En las casetas los pollos tienen los bebederos para que tomen agua, porque ésta ayuda al desplazamiento del alimento y/o ingesta, hasta cuando llegue el momento de agrupación.

Imagen 2. Salas de espera

Los representantes de las aerolíneas y los responsables de la logística en esta Crucialmente Importante Actividad son los encargados de organizar y hacer cumplir estrictamente los procedimientos establecidos, con el fin de que el desplazamiento de los pasajeros hacia el avión se realice rápido y ordenadamente dentro del tiempo determinado, generalmente una hora antes de retirarse la aeronave del túnel de abordaje.
Estudios han concluido que durante la prefaena se producen el 86% de los decomisos, que los inspectores de calidad situados en el área de evisceración detectan.
Origen decomisos
Cuando se decide iniciar la recolección, se levantan los bebederos, evitando que los animales se maltraten.
Cumplida esta fase, se inicia el agrupamiento de las aves, con el objeto de acercarlas al sitio donde se ubican los trabajadores quienes las atrapan por las patas o por el cuerpo, manteniendo las alas delicadamente pegadas al cuerpo, para impedir que aleteen efectuando una mínima presión sobre los sacos aéreos abdominales.
Si ésta no es la adecuada afectará su respiración normal.

Granja 67 % 14 % 19 %
Planta Atrape y cargue
Figura 1. Gráfica del origen de los decomisos, según datos de Aviagen Colombia.



Ventilación duradera y energéticamente eficiente para gallineros y porquerizas.
1 Materiales resistentes a la corrosión para un rendimiento duradero
2 3 4
Motor innovador con consumo energético reducido
Instalación optimizada y sencilla con un mínimo de componentes
Seguridad mejorada con accionamiento externo






















Descubre cómo mejorar tu sistema de ventilación con Oxsano en roxell.com











En los aeropuertos como en los galpones hay personas y aves respectivamente, con diferencias físicas y/o sanitarias – por ejemplo: Problemas de cojera, pododermatitis, etc.


Los funcionarios de las aerolíneas supervisan la entrada a la aeronave. En este caso, los pasajeros con algunas limitaciones físicas especiales tienen prioridad, facilitándole todas las implementaciones existentes: acompañantes que los movilizan, sillas de ruedas, quienes, dependiendo de las dificultades, los ayudan hasta localizar la silla asignada, etc.
De igual manera, el grupo de logística si detecta que en algunos galpones existen relevantes problemas de desuniformidad y limitaciones como antes mencionadas, tienen tratamientos especiales.
A medida que se van atrapando, se retornan al cerramiento las de menor tamaño y condiciones físicas limitantes.
Cumplido el enjaulado de las aves uniformes se continúa con los animales restantes – lamentablemente en algunas empresas los consideran desechos –, enfoque desafortunado desde el punto de vista humanitario como del negocio.
Son pollos con desarrollo muscular normal y su calidad es la adecuada para despacharlos a la planta. En muchas compañías que se identifican con los conceptos de la Gerencia Consciente, una vez procesadas, destinan su carne para segmentos de la población vulnerables por múltiples razones, comentadas en publicaciones anteriores.



Una solución de alimentación más inteligente
3 componentes:

Simple, eficiente y fácil de manejar
Totalmente lavable y desinfectable:
Limpieza profunda sin desmontaje
All-in-One use:
Ideal desde el primer día hasta el final del ciclo

Diseñado para el rendimiento
Bebederos con tetina 360°:
Disponibles con diferentes capacidades de agua para pollos de engorde y reproductores
Diseño simplificado:
Menos componentes para un montaje más rápido y fácil
Muestras preensambladas:
Kits listos para usar para compradores primerizos y facilidad de instalación desde el primer día
La filosofía es muy sencilla:
“Toda la carne apta para consumo humano se debe ofrecer a los segmentos de mercado apropiados”


Continuando con esta comparación didáctica, el avión es un gran recinto donde ingresan ordenadamente los pasajeros, evitando ocasionar la menor incomodidad posible.



El enjaulado es una operación crucialmente importante, ya que realizarla de manera desordenada ocasiona:
Si los pollos no se van distribuyendo en las jaulas primero en los laterales y los últimos en el centro, los que ingresan de primero y están acomodados van a manifestar su inconformidad, picoteando a los que van llegando. Resultado: Arañazos.
Una vez llena se ubica otra jaula encima. Si el llenado de ésta no se hace con el menor ruido posible alterará su tranquilidad, aumentando su estrés. Así mismo, la colocación de la siguiente vacía sin tirarla.
Completadas las pilas o arrumes de jaulas llenas deben desplazarse sobre una red de tubos que tengan conectores metálicos para asegurar siempre el paralelismo de los mismo. El grupo de trabajadores que realizan esta labor debe caminar – no correr -, para conservar la condición de confort que favorece un adecuado bienestar.
Si en el trayecto el destino final es llegar a la plataforma del camión o dejarlos a la salida del galpón debe hacerse un cambio de direccióngiro-, cuidadosamente para que no se golpeen, corriendo el riesgo de afectar su calidad Grado A, que es lo más importante.

INTERNO DE JAULAS
La organización de los arrumes de jaulas también reviste especial importancia.
Se deben alcanzar estos propósitos:
La movilización de las pilas completas debe llevarse a cabo sobre carritos con diseño especial que disminuyen significativamente la fatiga del personal, manteniendo un ritmo de trabajo constante.
Así mismo, se prolonga la vida útil de las jabas al no producirse desgaste acelerado, porque el piso o fondo de la caja no está en contacto con la plataforma del vehículo.
Este cuidado ha permitido que la duración de estos indispensables recipientes se haya extendido hasta 4 años.
En otros lugares se utilizan los mismos carritos, pero el recorrido se efectúa en dos tiempos. Esta práctica exige que dos personas levanten esta carga final en grupos de dos jaulas.
Esta operación perturba la comodidad y la tranquilidad adquirida a partir del momento en que fueron puestas en las jaulas.

Retomando la didáctica comparación, los pasajeros y las aves estaban debidamente acomodadas. Se inicia el viaje
A los pilotos se les entrega una información denominada Plan de Vuelo con todos los datos técnicos: velocidades, alturas y condiciones atmosféricas estimadas – pueden cambiar durante el vuelo sorpresivamente –, los pilotos deben hacer los ajustes pertinentes de común acuerdo con los controladores aéreos hasta llegar al aeropuerto sanos y salvos.
Los conductores de los camiones son profesionales experimentados que deben tener presente tres aspectos fundamentales para que la calidad del pollo que transportan no sufra deterioro alguno:
Las curvas deben transitarse a una velocidad máxima de 40 kph para minimizar el impacto que pueden sufrir las alas contra las paredes de las jaulas debido a la fuerza centrífuga.
Los reductores de velocidad deben pasarse con la inercia que trae el vehículo luego de una disminución gradual de la velocidad de crucero.
Beneficios: Los pollos no van a levitar lo suficiente cuando suban las llantas, golpeándose las espaldas, produciéndose hematomas. Adicionalmente, el impacto sobre las pechugas cuando bajen las llantas de esta superficie especial también será mínimo.
Cuando el estado de la carretera no es uniforme – grietas, huecos, etc. –, es necesario bajar la velocidad para que los sobresaltos que sentirán los pollos sean mínimos.

Aeropuertos: experiencias didácticas que ayudan a visualizar la reducción de los decomisos y desperdicios durante la prefaena
DESCÁRGALO EN PDF
¡Casque el futuro de los avances en avicultura, huevos, piensos y carne! Desde tecnología innovadora hasta redes globales, IPPE es el lugar donde las ideas eclosionan y usted puede descubrir miles de innovaciones para su negocio, dirigidas a la salud avícola, alojamiento, logística, empaques y mucho más. ¡No pierda la oportunidad de que el éxito eclosione en su negocio!
27-29 de enero de 2026. ATLANTA, GA, EE. UU.
HAZ TUS PLANES Y ÚNETE A NOSOTROS.
ASEGÚRATE DE INSCRIBIRTE EN IPPEXPO.ORG


En el mundo actual, la tecnología está integrada en casi todos los aspectos de nuestra vida —desde los teléfonos inteligentes hasta los hogares inteligentes—, ofreciendo comodidad, eficiencia e inteligencia en cada paso.
Estos avances se han vuelto parte natural de muchas industrias, y el procesamiento avícola no es una excepción.
Aunque la privacidad de los datos, la ciberseguridad y la complejidad de la transformación digital son desafíos legítimos, no son insuperables. Cada vez más procesadores avícolas en el mundo demuestran que, con la estrategia correcta, los socios adecuados y la mentalidad apropiada, es posible superarlos.

Un componente clave en esta transformación digital es la tecnología de visión, especialmente a medida que evoluciona con la inteligencia artificial (IA). Los sistemas de visión impulsados por IA brindan un nuevo nivel de flexibilidad y precisión, lo que permite a los procesadores tomar decisiones en tiempo real basadas en datos precisos y consistentes.

A medida que las empresas adoptan tecnologías avanzadas como la automatización, el análisis en tiempo real y los sistemas de visión mejorados con IA, están desbloqueando nuevos niveles de productividad, calidad y rentabilidad. Las soluciones digitales ya no son una consideración futura; son un motor actual de rendimiento y ventaja competitiva.
¿QUÉ
La industria avícola ha recorrido un largo camino, pasando de operaciones manuales e intensivas en mano de obra a líneas automatizadas de alta velocidad. En este entorno acelerado, la calidad constante del producto es fundamental. Tradicionalmente, los sistemas de visión se han utilizado después del enfriamiento para evaluar la calidad del ave entera, ofreciendo información valiosa, pero solo el uso final del ave.
Eso está cambiando. Los sistemas de visión impulsados por IA como ClassifEYE de BAADER están redefiniendo lo que es posible, permitiendo la captura de datos en tiempo real y decisiones más inteligentes basadas en datos durante toda la línea de producción. Su implementación ya no es solo una posibilidad, sino una necesidad para los procesadores que desean seguir siendo competitivos.



ClassifEYE no es solo otro sistema de cámaras. Es una herramienta inteligente que ofrece detección de calidad en tiempo real y a alta velocidad en múltiples puntos de la línea de procesamiento. Desarrollado internamente por BAADER, ClassifEYE utiliza IA para detectar anomalías en el proceso y defectos de calidad con precisión constante.
Así es como funciona:
Se capturan imágenes de alta resolución en ubicaciones clave.
Los algoritmos de IA analizan las imágenes usando modelos previamente entrenados y datos en tiempo real.
Los resultados se entregan al instante a través de paneles intuitivos, para que su equipo pueda actuar rápidamente.
Este sistema le permite detectar problemas cuando y donde ocurren. Ya se trate de desgarros en la piel, contaminación o defectos relacionados con las máquinas, ClassifEYE hace visible lo invisible. No hay que esperar hasta las etapas finales para identificar problemas de calidad. Obtiene la información que necesita, cuando la necesita.
Los datos de las cámaras se muestran mediante paneles intuitivos y personalizables para obtener información clara y procesable.
El verdadero poder de ClassifEYE radica en su capacidad de aprender y mejorar continuamente. Al mover la cámara a una nueva ubicación o introducir nuevas categorías de defectos, el sistema se adapta aprendiendo de datos etiquetados con precisión. Una vez entrenado, funciona de manera constante, incluso en entornos de alta velocidad.


Al ubicar unidades de ClassifEYE en puntos de control críticos—como máquinas individuales, al final de zonas de producción o etapas de transición—se obtiene visibilidad en todo el proceso.
Esto le permite:
Identificar la fuente exacta de degradados
Rastrear tendencias de calidad en áreas de producción (sacrificio, desplumado, eviscerado)
Comparar el rendimiento de las máquinas para optimizar las operaciones
Realizar mantenimiento predictivo basado en datos de rendimiento reales
¿El resultado? Más control, menos sorpresas y una reducción significativa de la pérdida de producto.


Ubicado después de la Cortadora de cloaca, la Abridora y la Evisceradora, ClassifEYE detecta problemas tempranos en el proceso, ayudando a evitar más productos desclasificados.
No hay dos plantas de procesamiento iguales, y por eso ClassifEYE está diseñado para crecer con usted. Ya sea que desee mejorar un área específica o transformar toda su instalación, el sistema se adapta sin problemas. Agregue cámaras. Expanda la cobertura. Profundice en el análisis de datos. El sistema se ajusta a sus necesidades, no al revés.
Entendemos la preocupación en torno a los datos: dónde van, quién puede acceder a ellos y cómo se protegen. Por eso BAADER integra la seguridad y la privacidad de los datos en el núcleo de sus soluciones. Usted mantiene el control total de sus datos, y nosotros garantizamos que estén protegidos, para que pueda centrarse en mejorar el rendimiento y la rentabilidad sin compromisos.

“En BAADER, hemos puesto un énfasis especial en desarrollar este revolucionario sistema de visión reuniendo un equipo dedicado de expertos en tecnología de visión, aprendizaje automático, ingeniería de software y procesamiento avícola. Lo que realmente distingue a esta solución es que ha sido construida en estrecha colaboración con procesadores avícolas, asegurando que responda a desafíos del mundo real y aporte valor tangible donde más importa.”
Comenta Michael Gillespie (Gerente Global de Producto, Plataformas, Automatización y Software)
“Este sistema introduce una nueva forma de controlar procesos críticos en la producción avícola. Permite a nuestros clientes optimizar continuamente el rendimiento y reducir las pérdidas con precisión y confianza.
También diseñamos la solución para que sea altamente flexible. Cualquier procesador que busque mejorar el control de producción puede comenzar con una sola unidad de procesamiento y escalar hasta 24 cámaras, ya sea de inmediato o de manera gradual, según las necesidades operativas.
Y, por supuesto, garantizamos que todos los datos estén protegidos mediante protocolos de seguridad robustos y estándares de la industria, resguardando las operaciones desde la planta hasta la nube.”
Comenta Michael Gillespie (Gerente Global de Producto, Plataformas, Automatización y Software)
¿LISTO PARA DAR EL SIGUIENTE PASO?
La IA no es una moda, es una herramienta, y en el procesamiento avícola, es una herramienta que ya está transformando cómo gestionamos la calidad, la productividad y la rentabilidad. ClassifEYE permite a los procesadores actuar más rápido, responder con mayor inteligencia y mejorar continuamente sus operaciones.
Así que, si se ha estado preguntando qué puede hacer la IA por su producción avícola, la respuesta es simple: puede hacer mucho, empezando hoy.
Para obtener más información sobre las soluciones digitales de BAADER, visite BAADER One.



La inteligencia artificial y la tecnología de visión transforman el procesamiento avícola
DESCÁRGALO EN PDF
Transformando el procesado con el uso de IA
La calidad del producto es clave en la industria avícola. Un control deficiente genera mayores costos, bajo rendimiento y daño a la marca. Para enfrentar esto, BAADER presenta una cámara de visión y sistema de informes que facilitan un control de calidad rápido y eficiente.
/ Detección precisa de calidad mediante tecnología de inteligencia artificial
/ El sistema opera a alta velocidad
/ Elimina la necesidad de mano de obra manual en control de calidad
/ Experiencia de usuario intuitiva
/ Información completa y fácilmente comprensible de la calidad
/ Información y análisis detallados que potencian la toma de decisiones informadas
Optimice su clasificación de calidad con una velocidad y eficiencia incomparables.


Dra. Priscila Esther Witrado Hurtado
Facultad de Medicina Veterinaria y Zootecnia de la Universidad Nacional Autónoma de México (UNAM)

La industria de gallinas reproductoras es fundamental para satisfacer la demanda global de proteína aviar, ya que provee huevos fértiles tanto para la producción de gallinas ponedoras como para pollos de engorde.
La producción de huevo y carne de pollo ha experimentado un crecimiento sostenido en los últimos años, reflejando la importancia de esta industria en el abastecimiento alimentario mundial.
El consumo per cápita de huevo y pollo continúa siendo elevado, destacando el papel crucial de la reproducción aviar para mantener la oferta.
La infertilidad en las aves reproductoras, tanto en hembras como en machos, puede afectar significativamente la productividad, elevando costos y reduciendo la disponibilidad de estos productos esenciales.
Esto impacta la sostenibilidad y rentabilidad de la industria avícola a nivel global.
Las causas de infertilidad en gallinas y gallos reproductores son variadas. En particular, la infertilidad en el gallo ha ganado mayor importancia en los últimos años debido a su impacto directo en la producción de huevo fértil para la cría de pollos de engorde.
Las principales causas de infertilidad pueden categorizarse en factores infecciosos y no infecciosos.
Las enfermedades que principalmente pudieran tener impacto en la fertilidad de las aves reproductoras son las respiratorias, ya que estas son de fácil diseminación y pudieran llegar a ser difíciles de detectar a tiempo.

Entre estas enfermedades están Bronquitis infecciosa, Micoplasmosis, Pneumovirus aviar, Coriza infecciosa e Influenza aviar de alta y baja patogenicidad.
Otras enfermedades, no respiratorias, que también pudieran llegar a causar un impacto en la fertilidad son Cólera aviar y Síndrome de baja postura.


Algunas de estas enfermedades están relacionadas directamente con afectaciones a nivel de oviducto, sin embargo, es importante señalar que cuando una gallina experimenta fiebre, normalmente debido a infecciones o inflamaciones (frecuentemente respiratorias), su organismo prioriza la respuesta inmunitaria, lo que puede causar

Este estado febril puede interferir en la correcta formación del óvulo, afectando el embrión desde la fertilización o incluso durante las primeras etapas de desarrollo.
Además, si el huevo fertilizado es producido bajo condiciones de fiebre o estrés, es más probable que el embrión presente fragilidad y que sus procesos de división celular y desarrollo se vean comprometidos, aumentando la mortalidad embrionaria. (Wilson, H.R., 1997).


Aspectos importantes que considerar en las enfermedades infecciosas:
Bronquitis infecciosa
Afecta tanto el tracto respiratorio como el reproductivo; daña el epitelio del oviducto y causa alteraciones en la calidad de la cáscara, lo que reduce la producción y la fertilidad.
Micoplasmosis (Mycoplasma gallisepticum/Mycoplasma synoviae)
Generan infecciones respiratorias crónicas y en el caso de Mycoplasma synoviae se afectan las articulaciones causando dificultad para desplazarse y llevar a cabo la cópula; causan una disminución en la tasa de postura y en la calidad del huevo, afectando la fertilidad.
Pneumovirus aviar
Conocido por causar problemas en vía respiratoria, lo cual disminuye el rendimiento reproductivo debido al debilitamiento del gallo o gallina.
Coriza aviar
Inflama el sistema respiratorio superior; el malestar general afecta el consumo de alimento y la energía disponible para la producción de huevo.

Influenza aviar
Enfermedad viral altamente contagiosa que provoca tanto signos respiratorios como sistémicos, también llega a dañar el epitelio del oviducto. Afectando la producción de huevos y la calidad de estos, con un impacto directo en la fertilidad.
Cólera aviar
La infección bacteriana causa alta mortalidad y síntomas sistémicos severos, lo cual compromete la capacidad reproductiva debido al deterioro del estado de salud del ave.
Síndrome de baja postura
Este virus afecta directamente el ovario y el oviducto, lo cual resulta en una reducción en la producción de huevos y problemas en la fertilidad.
Los factores no infecciosos pueden categorizarse con base a las semanas de edad de las reproductoras
Dentro de las principales causas de infertilidad en esta primera etapa se encuentran:
Uniformidad pobre
Si las gallinas llegan a producción con una pobre uniformidad y se adelantan en la madurez sexual, puede ocasionar bajos niveles de fertilidad debido a que pueden empezar con postura temprana y producir huevos más pequeños.
La selección de los machos tiene que ser muy estricta, eligiendo sólo aquellos con buen desarrollo y conformación músculo-esquelética, buena uniformidad, sin signos de enfermedad, mal emplumados y con monitoreo constante de error de sexado.
Relación incorrecta del peso macho:hembra
La relación mínima entre el peso de hembras y machos debe ser 1:1.2. Cada manual de estirpes o líneas de reproductoras tiene sus tablas de pesos de acuerdo con la edad del ave, por lo que un bajo o subida de estos pesos estándares recomendados afectaría la fertilidad

Estrés en la transferencia a las casetas de producción
Un mal manejo que genere mucho estrés en las aves al momento de transferirlas de la crianza a las casetas de producción puede generar impactos negativos en la fertilidad.
Igualmente, es importante recibir a las aves con el ambiente adecuado y proceder a familiarizarlas con los slats (rejillas), comederos y bebederos para que puedan alimentarse e hidratarse adecuadamente.

Es importante seguir las recomendaciones de la casa genética. Los machos se trasladan primero a las casetas y las hembras de 7 a 10 días después.
Importante recibirlos con equipos de alimentación diferenciados. Si no, al recibir dietas distintas, la fertilidad puede verse significativamente afectada.
Fotoperíodo incorrecto
Si el Fotoperíodo durante la crianza no fue adecuado, las aves no alcanzarán uniformemente la madurez sexual.
Aumento incorrecto de alimento después de la transferencia hasta el pico
Una sobrealimentación o aumentos rápidos en la alimentación pueden sobreestimular a las hembras, aumentando el riesgo de prolapsos, huevos grandes, de doble yema o huevos chicos.
La poca ventilación y acumulación de gases nocivos como dióxido de carbono y amoniaco generan impactos negativos en la fertilidad. También afectan la temperatura y la calidad de la cama.

Es importante ofrecer dietas nutricionales según la etapa: crianza, crecimiento o producción.
En producción, los machos requieren menor inclusión de energía, proteína y calcio comparado con las hembras.
Las hembras comen primero, y debe supervisarse que consuman su alimento en el tiempo estimado. También es importante la calidad y tamaño de partícula del alimento.








En esta etapa, los desafíos de fertilidad son causados por una sincronización sexual deficiente o estrés ambiental durante la fase de transferencia.
Las soluciones incluyen el manejo del estrés, ajustes en los incrementos de alimentación, y asegurarse de que los machos tengan una correcta conformación y desarrollo esquelético.
Cada estirpe cuenta con manuales de manejo establecidos por la casa genética, con fases de alimentación específicas por etapa.
La premezcla vitamínica debe ser de excelente calidad para garantizar una buena incubabilidad.
Dentro de las principales causas de infertilidad en esta primera etapa se encuentran:
Incorrecta relación macho:hembra
Es importante seleccionar nuevamente a los machos a esta edad, ajustar relaciones macho y hembra e incentivar la monta a través de spiking para evitar que la fertilidad decaiga.
Relación macho:hembra recomendada: 1:10
Hembras con mal emplume
Hembras que tengan mal emplume o mala calidad del plumaje van a rechazar la monta.
Revisar que las dietas tengan los macro y micronutrientes esenciales, revisar la ventilación de la caseta.
Es importante que las camas no estén húmedas para que las aves puedan tener comportamientos naturales como baños de tierra, o para que el plumaje no se humedezca ni se ensucie.
Mal control del peso de las hembras
Hembras con mayor peso tendrán problemas para la cópula y serán menos receptivas para los machos.
Revisar siempre la cantidad de ración o establecer restricción alimentaria en reproductoras pesadas.
Problemas nutricionales
En esta etapa persistirán los problemas si la calidad del alimento es deficiente.

Un mal balance de macro y micronutrientes afectará el rendimiento productivo de las hembras.

Una sensación ambiental agradable debe estar presente en todo momento para asegurar el mejor rendimiento productivo.
Monitoreo del flujo, velocidad y dirección del aire, monitoreo de la temperatura, monóxido de carbono y amoniaco.
Evitar que las aves se enfríen y monitorear la calidad de la cama para prevenir problemas en patas como pododermatitis.
En esta etapa, es clave cuidar a la hembra para que esté receptiva.
Los problemas surgirán por malas proporciones de apareamiento o una condición corporal inadecuada en las hembras.
Manejar la cobertura de plumas y la ventilación ayuda a que las hembras sean más receptivas al apareamiento.
Un mal manejo del macho afecta directamente la fertilidad de la parvada.
Es importante seguir haciendo selecciones, mínimo se tiene que reemplazar el 30% antes de agregar machos nuevos.
Seguir manteniendo la relación macho:hembra adecuada y hacer revisiones constantes a las características del macho: color de la cresta, conformación de la pechuga, emplume y salud de las patas.
Los reemplazos de machos deben provenir de lugares con buena bioseguridad, y asegurarse de que entren a producción con el peso adecuado (3.2 a 3.4 kg).
No aumentar de peso a los machos ni a las hembras, mantener siempre los pesos recomendados establecidos por las casas genéticas.


La regresión testicular del macho es natural conforme avanza la edad de la parvada, sin embargo, con técnicas como el monitoreo de los porcentajes de inclusión de las dietas y la selección de machos con base en su rendimiento productivo, se puede reducir la regresión testicular y mantener los niveles de fertilidad.
La infertilidad en aves reproductoras es un desafío multifactorial que involucra tanto causas infecciosas como no infecciosas, y cada etapa de desarrollo de las aves requiere un manejo especializado para maximizar la fertilidad.
La clave para resolver los problemas de infertilidad radica en una combinación de estrategias de manejo preciso y monitoreo continuo.
En esta etapa, las tasas de infertilidad aumentadas suelen deberse al envejecimiento de los machos (regresión testicular).
Las soluciones incluyen el manejo adecuado de los machos, el mantenimiento del peso corporal y la implementación del “spiking” (adición de machos más jóvenes) para mantener la fertilidad.
Desde una alimentación y peso controlados hasta un ambiente cuidadosamente regulado, cada detalle es fundamental para lograr una reproducción eficiente.
Además, el reemplazo planificado de machos y la sincronización de madurez sexual entre hembras y machos juegan roles cruciales en la mejora de la fertilidad
La atención meticulosa a cada fase del ciclo reproductivo y la aplicación de prácticas como el “spiking” para incentivar la parvada, aseguran que los niveles de producción se mantengan altos.
La prevención y control de enfermedades respiratorias y deficiencias nutricionales son esenciales para reducir la infertilidad y sostener la productividad avícola.


Causas de infertilidad en gallinas reproductoras DESCÁRGALO EN PDF
Grant Mason Geneticista de Aviagen

El año 2025 marca el aniversario de 22 años de la secuenciación del genoma del pollo. Han pasado 2 décadas desde que el pollo se convirtió en el primer animal agrícola cuyo genoma se secuenció por completo, un hito que transformó la crianza de aves de corral.
Pero ¿qué significa eso en realidad y por qué es importante?
El ácido desoxirribonucleico (o ADN) es la molécula portadora de las instrucciones genéticas utilizadas en las funciones biológicas de todos los organismos vivos.

Un genoma es un conjunto completo de material genético de un organismo, que sirve de manual de instrucciones para la vida. Todos los seres vivos, desde los humanos hasta los pollos, tienen uno y este contiene toda la información necesaria para el desarrollo y el funcionamiento general.
Los científicos llevan más de un siglo estudiando el ADN, pero la capacidad de leer el código genético completo de un organismo, lo que se denomina secuenciación del genoma, no fue posible hasta la década de los setenta.
Desde entonces, la investigación genómica ha avanzado rápidamente, lo que ha ayudado a los investigadores en una gran variedad de campos, desde la medicina hasta la agricultura.
¿Qué es la secuenciación del genoma y por qué es importante?
Secuenciar un genoma significa averiguar el orden exacto de los cuatro componentes básicos del ADN: A (adenina), T (timina), C (citosina) y G (guanina).
Considérelo como leer el libro entero de la vida de un organismo, letra por letra. Este conocimiento ha ayudado a los investigadores médicos a comprender enfermedades como el cáncer, lo que ha permitido mejorar los diagnósticos y los tratamientos.
En la cría de animales para la producción de proteínas, se han abierto nuevas posibilidades para producir animales más fuertes y sanos.
En 2003 se secuenció por completo el genoma del pollo, un emocionante avance que permitió a los científicos avícolas comprender mejor qué hace que un pollo prospere.
Un año más tarde, Aviagen puso en marcha su propio proyecto de genómica y dedicó más de ocho años a estudiar y optimizar los datos bioinformáticos y los modelos estadísticos antes de poner en práctica estos conocimientos*. Este trabajo nos ha ayudado a criar aves con fortalezas naturales: mejor salud, mayor bienestar y un desempeño superior.
Al estudiar el ADN de un pollo podemos identificar cualidades que contribuyen a su buena salud y productividad, como patas fuertes, aptitud reproductiva y crecimiento sano.

Estos conocimientos nos permiten realizar selecciones precisas y equilibradas en nuestros programas de crianza, basándonos en generaciones de crianza cuidadosa para mejorar el bienestar y la sostenibilidad del ave.
La genómica ha mejorado la forma en que medimos rasgos difíciles de ver, dándonos una imagen más completa del potencial de cada ave.
Por ejemplo, ha ayudado a mejorar la selección para la eficiencia con el alimento, los rasgos reproductivos, la mejora del sistema inmunitario y el crecimiento.
e ciencia alimentaria características reproductivas
sistemas imunológicos
Crecimiento de las aves
También ayuda a que las predicciones de crianza sean más precisas, especialmente en el caso de rasgos que solo se aplican a un sexo, como la selección de machos basada en el potencial de producción de huevos.
Cuando combinamos estos datos con la selección práctica tradicional, podemos avanzar de manera constante en la crianza de aves que no solo sean productivas, sino también robustas.
Este avance científico ha reconfigurado la crianza de aves de corral y ha ayudado a la industria a seguir el ritmo de una demanda mundial cada vez mayor de aves de corral sostenibles y de alta calidad.
Al tomar decisiones informadas sobre la crianza, no solo mejoramos la salud y el bienestar de los animales, sino que también garantizamos una producción sostenible de carne de ave.
Cómo 22 años de genómica están moldeando el futuro de la avicultura DESCARGAR EN PDF
*Es importante destacar que el programa de crianza de Aviagen se basa en la selección natural y no implica modificación genética.


Impulsar innovación y progresos en la industria avícola para un futuro sostenible.




Vinicius Santos Moura Doctorado en el departamento de Zootecnia de la Universidad Federal de Grande Dourados

Debido a la alta demanda de proteína animal, se vuelve necesario aumentar el número de aves alojadas en el campo, con el único objetivo de producir un producto final de calidad.
Sin embargo, la producción de estos animales no se inicia con la recepción de los pollitos, sino con la correcta selección y el adecuado proceso de incubación de huevos fértiles.
El proceso de desarrollo de los pollitos comienza con el cruce adecuado entre reproductoras y gallos, y como resultado de esto, se espera obtener huevos con características que favorezcan el desarrollo embrionario y, por tanto, la producción de pollitos viables.

Dentro de este escenario, factores como la nutrición maternal, la composición interna de los huevos, la calidad externa de los huevos, la carga microbiológica, el estatus del desarrollo embrionario y las condiciones de almacenamiento de estos huevos en un ambiente controlado desempeñan un papel fundamental en el éxito de la incubación.
Además, diversos parámetros asociados al equipo utilizado influyen en el éxito final del proceso, tales como la temperatura, el volteo adecuado de los huevos, la humedad relativa, la eliminación de gases tóxicos, así como la limpieza y desinfección previas de la incubadora.
En el caso del uso de incubadoras de etapa múltiple, el ajuste de la temperatura se realiza mediante el calor generado por los propios embriones.
En este tipo de proceso, los huevos se encuentran en diferentes etapas de desarrollo, lo que requiere el manejo de distintos rangos de temperatura, niveles de oxígeno y la adecuada eliminación de gases como el amoníaco y el dióxido de carbono, con el fin de satisfacer las demandas metabólicas de los embriones.
Algunos autores indican que los embriones más avanzados producen temperaturas que favorecen el proceso de incubación, pero que, a su vez, generan un ambiente que provoca estrés térmico en los embriones en etapas menos desarrolladas, aumentando la mortalidad embrionaria y, en algunos casos, ocasiona una maduración tisular inadecuada debido al estrés oxidativo que afecta a las células en desarrollo.
Además, es fundamental considerar el impacto de la contaminación microbiológica sobre la calidad de los huevos.
En incubadoras que operan con etapa única, es posible ajustar el proceso a huevos que se encuentran en el mismo estadio de desarrollo, lo que favorece un ambiente físico mejor controlado.
Araújo et al. (2016), al trabajar con incubación en etapa única y múltiple utilizando huevos provenientes de reproductoras de diferentes edades, observaron que no hubo diferencias en la tasa de eclosión al considerar las variables edad, tipo de incubadora y eclosionabilidad. Esto demuestra que, independientemente del equipo utilizado, ambos tipos de incubadoras pueden satisfacer los requerimientos de los embriones.

También observaron que hubo una diferencia en la tasa de eclosión relacionada con la edad de los progenitores, dejando en evidencia que esto se debe a la disminución en la calidad de la cáscara del huevo, lo cual interfiere directamente en la acción de los parámetros físicos de la incubadora sobre el desarrollo de los pollitos.
Uno de los factores señalados por estos autores es la ventana de nacimiento, que se ve afectada por el tipo de incubadora. Al hablar de ventana de nacimiento, se debe considerar el momento en que eclosiona el primer huevo y las horas restantes en la nacedora que se incluirán dentro del proceso, para la clasificación de pollitos viables al momento en la eclosión.
En este contexto, si consideramos a aquellos pollitos que eclosionan en las primeras horas, se observa una deshidratación más rápida, un uso acelerado de los sustratos presentes en la yema y un secado más eficiente del plumón, lo que lleva a que estos pollitos sean considerados de mejor calidad en comparación con aquellos que nacen en las últimas horas de la ventana, al momento de realizar el análisis de calidad.
Mesquita et al. (2021) notaron una diferencia en la pérdida de peso de los huevos al final de la incubación, siendo mayor en incubadoras de etapa múltiple, lo cual podría estar relacionado con la regulación del calor por parte de los huevos en estadios embrionarios más avanzados.
Los autores no observaron diferencias en cuanto al peso del pollito al momento de la eclosión, ni en relación con el porcentaje que representa el peso del pollito respecto al peso del huevo.

Sin embargo, identificaron diferencias significativas al evaluar ciertos parámetros en el momento de la extracción de la nacedora, como el peso al nacimiento, peso corporal sin la yema, el peso corporal sin la yema en relación con el peso del huevo y el tamaño del pollito, siendo todos estos valores superiores en pollitos provenientes de incubadoras de etapa única.
Además, los autores señalaron una mejor calidad en los pollitos provenientes de incubadoras de etapa única en comparación con los de etapa múltiple.
Diversos autores también relatan que la temperatura dentro de una incubadora varía según la posición de las bandejas, y que el desarrollo de los embriones está asociado con las microregiones existentes dentro de la incubadora.
Tejeda, Melhoche y Starkey (2021) no observaron diferencias en el consumo de alimento, conversión alimenticia, ganancia de peso ni la mortalidad final después de 41 días de crianza de las aves, en función de la ubicación de la bandeja de huevos dentro de la incubadora.
El rendimiento de la reproductora Hubbard comienza temprano y continúa hasta el final del ciclo. Genética desarrollada para obtener GPD consistente con reproductoras que preservan altos índices reproductivos.
Resultado para quien produce, valor para toda la cadena.
www.hubbardbreeders.com



Algunos estudios demuestran que, a medida que aumenta el tiempo de almacenamiento de los huevos, también se incrementa la pérdida de peso de estos debido a la deshidratación, además de observarse embriones en diferentes etapas de desarrollo. Esto ocurre, en muchos casos, debido a la necesidad de reunir un número específico de huevos antes de iniciar el proceso de incubación.
Por esto, surge la necesidad de trabajar en ambientes controlados, aplicando el “cero fisiológico”, un proceso que busca regular el desarrollo embrionario de manera adecuada, garantizando una menor deshidratación del huevo y, en consecuencia, una ventana de nacimiento más reducida y una mejor calidad de los pollitos.
Bilalissi et al. (2022), al investigar los efectos del tiempo de almacenamiento de los huevos y las condiciones de ventilación en incubadoras sobre el desempeño de pollos de engorde, verificaron que el peso de los huevos disminuyó a medida que aumentaba el tiempo de almacenamiento (7 vs. 18 días).
Al comparar los pesos de los huevos al inicio de la incubación, los huevos almacenados durante 7 días presentaron un peso superior en comparación con los almacenados durante 18 días, independientemente del tipo de incubadora (ventilada o no ventilada).
En cambio, no se observaron diferencias en el peso de los huevos cuando se compararon los mismos tiempos de almacenamiento (7×7 o 18×18), sin importar el tipo de ventilación.
Lo que sí se observó fue una mayor tasa de eclosión en los huevos almacenados durante 7 días, así como un mejor peso y calidad al nacimiento, independientemente del tipo de ventilación de la incubadora.
Tras lo expuesto, se evidencia la necesidad no solo de conocer los factores físicos que interfieren en el proceso de incubación, sino también de reflexionar sobre cómo estos factores, en conjunto con la genética, nutrición y microbiología, pueden favorecer mejores tasas de fertilidad, eclosión y calidad de los pollitos tras el proceso de incubación.
Pensar en la incubación implica conectar toda la cadena productiva, buscando alternativas para maximizar la producción y garantizar la competitividad en el mercado avícola.

Implicaciones y resultados del proceso de incubación sobre la calidad de los pollitos DESCÁRGALO EN PDF
Referencias disponibles a solicitud del autor.
Se dice que la primera impresión es fundamental y, en nuestra industria, esto está relacionado con la calidad del pollito a la llegada de la granja.
Teniendo esto en cuenta, es muy importante contar con los procedimientos y herramientas que nos ayuden a evaluar la calidad de los pollitos en la planta de incubación, pero también al llegar a la granja y así poder hacer las correcciones para mejorarla.


En la planta de incubación es fundamental comprender si las condiciones de incubación fueron óptimas y, cuando sea necesario, hacer las correcciones para mejorar y asegurar que se envíe la mejor calidad a los clientes.

Por otro lado, durante el alojamiento, es importante no solo evaluar si la incubación fue buena, sino también verificar si las condiciones de almacenamiento y transporte fueron óptimas y, además, asegurarnos de que estamos recibiendo la mejor calidad.
administradores de criaderos y granjas para evaluar la calidad de los pollitos. Este documento organiza los factores en tres categorías: preincubación, incubación y post incubación.

Factores de preincubación que impactan en la calidad de los pollitos:
Nutrición de las reproductoras.
Estado de salud de las reproductoras.
Calidad de los huevos para incubar.
Almacenamiento de huevos y transporte a la incubadora.
Factores de incubación que impactan en la calidad de los pollitos:
Ambiente de incubación (temperatura, oxígeno, CO 2, ventilación, etc.).
Temperatura de la cáscara del huevo.
Transferencia.
Ventana de eclosión.

Como puede imaginar, la calidad de los pollitos comienza en la granja de reproductoras y finaliza unos días después del alojamiento. En este documento técnico revisaremos los factores más importantes que impactan en la calidad y cómo pueden evaluarlo los responsables de la incubadora en el momento del nacimiento y los granjeros en el momento del alojamiento.


La calidad del lote de reproductores determina la calidad del huevo incubable
Sacarlos a tiempo.
Factores post incubación que impactan en la calidad de los pollitos:
Condiciones post nacimiento en incubadora (temperatura, humedad, ventilación y luz).
Condiciones de transporte (temperatura, ventilación y humedad).
Condiciones de crianza durante los primeros cuatro días después del alojamiento.
En esta primera parte, desglosaremos los factores de pre-incubación que impactan en la calidad de los pollitos

Por ejemplo, un mal manejo de la alimentación que afecta el rendimiento y la calidad de la cáscara del huevo.
A medida que el lote envejece, la calidad de la cáscara del huevo disminuye. Mientras que las gallinas menores de 30 semanas de edad podrían producir pollitos más inmaduros que requieren las mejores condiciones de crianza (desarrollo del sistema termorregulador) y las gallinas mayores de 67 semanas producen huevos de peor calidad (calidad de cáscara y calidad interna).

Cualquier enfermedad que afecte la calidad de la cáscara del huevo y/o la calidad interna (bronquitis infecciosa) y la calidad y viabilidad del pollito (Salmonella spp, Escherichia coli, Mycoplasma, virus de la anemia del pollo, encefalomielitis aviar, etc.).

Es fundamental seguir los niveles recomendados de vitaminas y minerales de la guía de manejo porque no seguirlos podría dañar la calidad y fertilidad de los pollitos y/o la incubabilidad. Siempre revisa la etiqueta de la premezcla de vitaminas/minerales.
Esto es aún más crítico en condiciones de clima cálido y/o en situaciones de caída en el consumo de alimento.
Un agua subóptima podría llevar enfermedades, toxinas o altos niveles de minerales. Es sumamente importante verificar la calidad microbiológica del agua y una desinfección constante para prevenir bacterias o virus.
Incubar huevos de al menos 50 g y de lotes de al menos 22 semanas de edad. Lo óptimo es incubar lotes de huevos con un peso promedio de 58 a 61 g (comience con 50 a 52 g) con buena uniformidad (>90%).
Esto contribuye a tener una buena incubabilidad, ventana de nacimiento y calidad de los pollitos.
Dependiendo de la anomalía es el grado de impacto en la incubabilidad (ver Tabla 1). Incubar únicamente huevos con forma normal.
Anomalía % Incubabilidad
Normal 74
Puntiagudo 65
Redondo 63 Pequeño 62
Con gránulos 19 Arrugado 13
Tabla 1. Características de los huevos y el impacto en la incubabilidad. Adaptado de Banday y Bakat, 2014 3 6 4 5

DEL HUEVO: Una buena cáscara proporciona protección, una fuente óptima de Ca y homeostasis para un buen desarrollo embrionario. La edad, la nutrición, la estación y el manejo del lote influyen en la calidad de la cáscara del huevo.
Los huevos con peor calidad de cáscara son más susceptibles a la contaminación bacteriana afectando la calidad del pollito (ver Gráfico 1).

específica
Gráfico 1. Porcentaje de huevos de diferentes calidades de cáscara que contienen Salmonella viable 24 horas después del desafío por Salmonella spp. Cuanto mayor sea la calidad específica, mejor será la calidad de la cáscara del huevo. Adaptado de Sauter y Petersen, 1974
de huevo Bacterias
HUEVOS LIMPIOS: Utilice
únicamente huevos limpios. Nunca utilice huevos del suelo.
Para prevenir huevos en el suelo y mejorar la utilización del nido, es fundamental lograr un buen entrenamiento en la crianza.

Las enfermedades, nutrición, calidad del agua, manejo, limpieza del nido (y de las cintas de huevos) y las características del equipo juegan un papel importante en tener huevos limpios.
Al incubar huevos sucios existe el riesgo de que nazcan pollitos que pueden tener una alta mortalidad debido a enfermedades bacterianas (ver Gráfico 2 y Tabla 2).
Tabla 2. Efecto de la limpieza de los nidos sobre el recuento de bacterias y la mortalidad acumulada en la segunda semana. Adaptado de Mauldin, 2008 (engormix.com).
Mortalidad acumulada en 2ª semana
Gráfico 2. Impacto del grado de limpieza del nido en la mortalidad acumulada a la segunda semana. Adaptado de Mauldin, 2008 (engormix.com).
ALMACENAMIENTO DE HUEVOS:
Cuanto más tiempo se almacene, peor será la calidad del pollito. La investigación realizada por Tona (2003) demostró que cuanto mayor es el tiempo de almacenamiento de los huevos para incubar, peor es la calidad de los pollitos (ver Gráfico 3).
Además, el aumento de peso corporal 7 días después del alojamiento es menor en los pollitos nacidos de huevos almacenados durante un período prolongado (> 14 días).
3 días 18 días
Pollitos con puntuación del 100% Días de almacenamiento
Gráfico 3. Efecto de los días de almacenamiento sobre la calidad del pollito. Adaptado de Tona et al., 2003.

Se puede utilizar un período corto de incubación durante el almacenamiento de huevos (SPIDES) para mitigar el impacto del almacenamiento prolongado.
TRANSPORTE DE HUEVOS
PARA INCUBAR
Transportar los huevos para incubar en camión limpio y desinfectado. Exclusivo para el transporte de huevos para incubar.
La temperatura debe ser de 18 a 22°C y la humedad relativa (HR) del 40 al 60%.
Se debe evitar a toda costa la condensación en la cáscara del huevo porque la humedad en la cáscara del huevo perjudica el mecanismo natural de defensa del huevo contra los microorganismos y proporciona condiciones óptimas para la multiplicación de los estos.
Temperatura de la sala de almacenamiento y de la cáscara del huevo

Temperatura fuera de la sala de almacenamiento
Factores que afectan a la calidad del pollito: Parte I DESCÁRGALO EN PDF 7
Tabla 3. Predicción de si se producirá condensación si no se toman medidas adicionales. Adaptado de Gerd de Lange, 2011 (poultrysite.com). Para un rango más amplio de temperaturas y humedades, utilice un gráfico psicométrico.
La Tabla 3 se puede utilizar para predecir condensación cuando no se tomen medidas adicionales. Desinfección constante para prevenir bacterias o virus.
Conmemoramos 80 años de excelencia en genética avícola, impulsando la productividad y calidad en la producción de huevos.
Agradecemos la confianza de nuestros clientes y aliados a lo largo de este camino.
Atte. Equipo H&N International


Hans Mann, Ingeniero Agronomo Zootecista
Instituto Tecnológico y de Estudios Superiores de Monterrey

El cascarón del huevo es una estructura compleja y esencial que asegura la integridad del huevo. Su estudio abarca aspectos biológicos, estructurales y productivos, clave para mejorar la calidad y seguridad alimentaria. Este texto analiza su formación, composición y la evolución tecnológica en la industria avícola moderna.

El huevo de gallina, en forma de huevos de plato o de sus productos, constituye una parte básica del consumo de proteínas en muchos países del planeta.
Desde hace más de un siglo, se han intensificado los estudios para comprender cómo se forma el huevo, optimizar su producción y mejorar su calidad.
Con la incorporación de nuevas tecnologías moleculares, también se ha avanzado en el conocimiento de los procesos biológicos que intervienen en la formación del óvulo y las funciones específicas de cada uno de sus componentes.
Históricamente, el ser humano ha utilizado los huevos como alimento, pero no fue sino hasta épocas recientes que se empezó a aprovechar plenamente su potencial nutricional e industrial.
A comienzos del siglo XX, las gallinas maduraban entre los seis y nueve meses y producían entre 100 y 180 huevos anuales.
Con mejoras en la genética, nutrición, sistemas de cría e iluminación artificial, esa cifra aumentó notablemente: de 130 huevos por gallina en 1940 a 260 en 1980, 300 en el año 2000 y hasta 520 en un ciclo de 100 semanas, según datos actuales.
En cuanto a la calidad del huevo, entre 1981 y 1991 se buscó controlar su peso conforme a la edad de las gallinas, además de mejorar el color y el grosor del cascarón.
Luego, se logró incrementar la masa de huevo producida sin aumentar el peso corporal del ave.
A partir de 1995, la creciente demanda de ovoproductos líquidos y los requisitos de calidad certificada impulsaron a las empresas genéticas a incluir propiedades tecnológicas de la albúmina en sus programas de selección.

La cáscara del huevo de la gallina es una estructura policristalina altamente ordenada y fue descrita por primera vez por Von Nathusius (1821-1899). En esencia, la cáscara del huevo de la gallina se compone de seis capas, incluyendo:
Poro Capa de cristal vertical

Cutícula externa
Capa de empalizada
Protuberancias mamilares
Membrana alantoidea interna
Membrana alantoidea externa
La calcita (carbonato de calcio) es el principal componente mineral, organizada con alta orientación cristalina, lo que otorga a la cáscara resistencia mecánica excepcional, con una fuerza de rotura de 35 N para un grosor promedio de 0.33 mm.
Las membranas alantoideas interna y externa forman las dos capas más internas. La zona interna de la parte calcificada del cascarón está compuesta por conos irregulares o protuberancias mamilares, cuyas puntas son penetradas por las fibras de la membrana externa.
La capa de empalizada, que da lugar a la parte más gruesa del cascarón calcificado, se extiende más allá de las bases fusionadas de la capa mamilar y termina en una fina capa de cristal vertical donde los cristales de cristalito están alineados perpendicularmente a la superficie del cascarón.
La capa más externa de la cáscara, la cutícula, es una capa orgánica depositada en la superficie de la capa de cristal vertical. Contiene una película delgada de cristales de hidroxiapatita en su zona interna y la mayor parte de los pigmentos superficiales de la cáscara de huevo.














Todas las cáscaras de huevo de las aves comparten el mismo componente mineral, el carbonato de calcio (CaCO3), en su forma trigonal conocida como calcita, el polimorfo más estable a temperatura ambiente.

Los cristales de calcita dentro de la cáscara muestran una orientación preferida, con el eje C tendiendo a ser perpendicular a la superficie de la cáscara en su región superior.
Este alto grado de control del tamaño, forma y orientación de los cristales es responsable de su ultraestructura única y sus propiedades mecánicas, como una resistencia a la rotura de 35 N para un grosor de 0.33 mm.
El grosor de la cáscara del huevo, su forma, tamaño y los elementos estructurales, así como las características del sistema poroso varían entre las diferentes especies, sin embargo, la estructura general es básicamente la misma en todas las aves.
La cáscara del huevo se forma a temperatura corporal en un espacio confinado, dentro del segmento distal del oviducto en un líquido uterino acelular supersaturado de calcio y bicarbonato, de 80 a 120 veces mayor que el producto de solubilidad de la calcita. Este medio contiene los precursores orgánicos de la matriz de la cáscara.
El carbonato de calcio precipita espontáneamente en forma de calcita, promovido por los componentes orgánicos.
El crecimiento inicial de los cristales ocurre en sitios específicos de semillas en las membranas de la capa externa que consisten en agregados orgánicos, y luego continúa para formar la capa mamilar.
Posteriormente, las mamillas se fusionan para formar la base de la capa de empalizada, donde solo los cristales perpendiculares a la superficie pueden seguir creciendo.
El crecimiento anisotrópico de los cristales de calcita es controlado por los componentes de la matriz orgánica, especialmente por proteínas como ovocalixinas y ovocleidinas, que han sido ampliamente estudiadas y se ha demostrado su rol en la formación de la cáscara del huevo.
El grosor es un factor principal en la resistencia mecánica, pero también lo son la organización estructural, la microestructura y la orientación cristalográfica.
Los conos mamilares están compuestos por cristales pequeños y sin orientación privilegiada, mientras que en la capa de empalizada (de unos 200 micrómetros), los cristales aumentan su tamaño y se alargan a lo largo del eje c de la calcita.
Su tamaño lateral aumenta desde 20 micrómetros hasta aproximadamente 80 micrómetros.
Ensayos de nanoindentación muestran una dureza y módulo elástico decrecientes desde la superficie hacia el centro.


La ultraestructura de la cáscara es regular, constituida por calcita como único polimorfo, formando una cerámica policristalina.



El metabolismo del calcio relacionado con la formación de huevos es muy dinámico, ya que no hay almacenamiento previo en la glándula de la cáscara.
El calcio proviene del calcio iónico de la sangre, aportando diariamente los 2 g necesarios para la cáscara, lo cual representa un desafío metabólico importante para una ave que pesa menos de 2 kg.

Este calcio se obtiene por absorción intestinal y por movilización ósea, debido a la desincronización entre la ingesta diurna y la formación nocturna de la cáscara.
Las aves disponen de hueso medular como reservorio de calcio, que constituye un 12% del calcio óseo total. Su formación es inducida por estrógenos y testosterona dos semanas antes de la postura.

Figura 2. Diagrama aproximado del metabolismo del calcio
Boca
Durante la formación de la cáscara, la resorción ósea medular se incrementa 9 veces, pero también la actividad osteoblástica se duplica para renovarlo.
Zona de absorción Cloaca
Ca fecal Ca dietario
Ca en sudor Deposición de

(Ca endógeno + Ca absorbido)
engógeno
La matriz orgánica juega un papel crucial en la formación del cascarón y sus propiedades mecánicas. Contiene proteínas y proteoglicanos con afinidad por el calcio, como los que contienen sulfatos de queratán o dermatán.
Las proteínas del líquido uterino también tienen esta afinidad, comprobada mediante electroforesis.
En condiciones comerciales, las fuerzas que causan la rotura del huevo pueden ser por impacto o aplastamiento. Ambos tipos presentan una relación significativa entre grosor del cascarón y porcentaje de huevos agrietados. Sin embargo, el grosor solo influye parcialmente.
La variación del grosor es mayor entre los polos que en la latitud, por lo que los huevos se agrietan más fácilmente a lo largo del eje longitudinal.
La fracción orgánica soluble del cascarón y del líquido uterino modula la precipitación del carbonato de calcio de manera dosis-dependiente.
Se concluye que el polo ancho tiene mayor resistencia al impacto que el polo estrecho, y que la resistencia varía entre estirpes de aves.
La rotura del cascarón representa una pérdida económica constante para la industria avícola. Es fundamental comprender la resistencia del huevo desde la ovoposición hasta el consumidor.

La calidad de la cáscara es clave para la seguridad alimentaria y mantenerla durante ciclos largos de producción (hasta 100 semanas) representa un gran desafío para la industria.
*Referencias disponibles a solicitud del autor.
Cascarón del Huevo: Pilar de la calidad en la industria avícola moderna DESCÁRGALO EN PDF

Edgar O. Oviedo-Rondon Prestage Department of Poultry Science, North Carolina State University

La mayoría de las parvadas avícolas se crían en condiciones intensivas, lo que incrementa la necesidad de control microbiano. En las últimas décadas, el uso continuo de diversos productos antimicrobianos para prevenir y tratar patógenos ha aumentado el riesgo de resistencia a los antimicrobianos (RAM) en la cadena de producción avícola.
Cuando se exponen a productos utilizados para su control, la RAM se desarrolla en bacterias, hongos, parásitos y virus como parte de un proceso evolutivo natural.
Al hablar de RAM, se deben incluir todos los microorganismos, no solo las bacterias.
Sin embargo, la resistencia a los antibióticos en el control de bacterias ha recibido más atención.
2
Existen dos vías principales asociadas con la evolución y el desarrollo de la RAM.
La primera está relacionada con la resistencia mediada por fenotipos preexistentes en poblaciones bacterianas naturales.

Durante el proceso evolutivo, las bacterias acumulan errores genéticos en genes existentes dentro del cromosoma bacteriano o plásmidos, y transfieren esos determinantes genéticos responsables de la resistencia innata/natural o intrínseca a las células de la progenie a través de la transferencia vertical de genes.
El segundo escenario se refiere a la resistencia adquirida mediante mecanismos de transferencia horizontal de genes que pueden ocurrir entre las mismas o diferentes especies bacterianas.
Esta transferencia genética horizontal se puede desarrollar mediante una vía directa que implica mutaciones genéticas, o una vía indirecta por medio de la adquisición de fragmentos de ADN que codifican resistencia, conocidos como transposones, integrones, fagos, plásmidos o secuencias de inserción. La vía horizontal ocurre a través de conjugación, transformación o transducción. Estos son mecanismos biológicos para la transferencia de dichos genes.
La RAM puede provocar fallos en el tratamiento de las parvadas avícolas, lo que conlleva pérdidas económicas para los productores. Sin embargo, la principal preocupación es que las aves de corral puedan convertirse en una fuente de bacterias y genes resistentes, y que las bacterias zoonóticas pueden suponer un riesgo para la salud humana.
La RAM es una amenaza global
La RAM es una de las principales amenazas globales para la salud pública y el desarrollo. Las fuentes primarias de desarrollo de la RAM son los productos terapéuticos, especialmente los antibióticos, para uso humano en hospitales, y la contaminación del agua.
No obstante, se ha demostrado que el uso de antibióticos para la prevención y el tratamiento de enfermedades animales contribuye al aumento del problema de la RAM.
Solo en EE.UU. se producen más de 2,8 millones de infecciones por RAM al año.
Más de 35.000 personas mueren como consecuencia, según el Informe sobre Amenazas de Resistencia a los Antibióticos 2019 de los CDC.
La RAM pone en riesgo muchos de los avances logrados en la medicina moderna. Esto hace que las infecciones sean más difíciles de tratar y vuelve otros procedimientos y tratamientos médicos, como cirugías, cesáreas y quimioterapia contra el cáncer, considerablemente más arriesgados.

La Carga Global de Enfermedad (GBD, por sus siglas en inglés) pronostica que 191 millones (156–226 millones) de muertes podrían ser atribuibles a la RAM, y que 822 millones (685–965 millones) de muertes asociadas a la RAM podrían ocurrir a nivel mundial hasta el año 2050.
Se proyecta que, para el año 2050, las superregiones con las tasas más altas de mortalidad por resistencia antimicrobiana (RAM) en todos los grupos etarios serán Sudeste Asiático, América Latina y el Caribe. El incremento más significativo en muertes atribuibles a la RAM se registrará en personas mayores de 70 años.
Además de la muerte y la discapacidad, la RAM conlleva costos económicos significativos para las sociedades. El Banco Mundial estima que la RAM podría generar US$1 trillón en costos adicionales de atención médica para 2050 y entre US$1 trillón y US$3,4 trillones en pérdidas anuales del producto interno bruto (PIB) para 2030.
Por lo tanto, es crucial prestar más atención a este tema en la industria avícola y evitar contribuir al problema.

Se ha identificado un aumento en la detección de aislamientos con resistencia antimicrobiana (RAM) en patógenos comunes de las aves de corral, como Escherichia coli (APEC), Salmonella Pullorum/Gallinarum, Pasteurella multocida, Avibacterium paragallinarum, Gallibacterium anatis, Ornithobacterium rhinotracheale (ORT), Bordetella avium, Clostridium perfringens, Mycoplasma spp., Erysipelothrix rhusiopathiae y Riemerella anatipestifer.
Entre las bacterias de la familia
Enterobacteriaceae, los aislamientos APEC mostraron niveles significativamente más altos de RAM en comparación con S. Pullorum/Gallinarum, con prevalencias de resistencia superiores al 80% para ampicilina, amoxicilina y tetraciclina en diversos estudios.
Entre los patógenos Gram negativos no Enterobacteriaceae, el ORT mostró los niveles más altos de resistencia fenotípica, con niveles medios de RAM contra cotrimoxazol, enrofloxacina, gentamicina, amoxicilina y ceftiofur que superaron el 50%.
En contraste, los niveles de resistencia entre los aislados de P. multocida fueron inferiores al 20% para todos los antimicrobianos.
Estas condiciones pueden variar considerablemente entre regiones, empresas y explotaciones agrícolas, dependiendo del historial de uso de antibióticos.

Un factor crítico en los sistemas de producción avícola que utilizan antibióticos es la contaminación del medio ambiente cuando los residuos de estos fármacos son liberados al entorno, contaminando el suelo y las fuentes de agua. Las mejoras en los sistemas de tratamiento de aguas residuales y desechos pueden ayudar a minimizar esta amenaza.
Para combatir la RAM, los productores avícolas en todo el mundo han venido restringiendo el uso de antimicrobianos durante las últimas tres décadas, al mismo tiempo que adoptan prácticas de producción libre de antibióticos (ABF, por sus siglas en inglés) y orgánica para satisfacer las demandas de los consumidores.
No obstante, la RAM continúa emergiendo y propagándose sin respetar fronteras.
Aunque aún no existe un consenso definitivo sobre la contribución del uso de antibióticos en animales destinado al consumo humano al desarrollo de la RAM, estudios epidemiológicos y moleculares indican una conexión entre el uso de antimicrobianos y la aparición de cepas bacterianas resistentes en animales, así como su diseminación hacia los seres humanos a través de la cadena alimentaria.
Las intervenciones para restringir el uso de antibióticos en aves de corral se han relacionado con una reducción en la RAM.

Sin embargo, aún se comprende poco cómo las prácticas de producción ABF, orgánica y alternativas a los antibióticos promotores del crecimiento influyen en los perfiles de RAM del microbioma intestinal de las aves de corral.
Se han reportado diversas bacterias Gram negativas (Salmonella enterica serovars, Campylobacter jejuni/coli, E. coli) y Gram positivas (Enterococcus spp., Staphylococcus spp. y Clostridium perfringens) que albergan múltiples determinantes de RAM en aves de corral, incluyendo tanto pollos criados orgánicamente como en sistemas ABF. Ahora bien, la prevalencia de RAM es claramente menor en los sistemas ABF.
Además de la variedad de aditivos comunes presentes en la alimentación que actualmente se utilizan para modular parcialmente el microbiota de las aves, están surgiendo dos nuevas categorías con potencial para contribuir al control de bacterias con resistencia antimicrobiana (RAM): los péptidos antimicrobianos y los bacteriófagos. Sin embargo, sus altos costos de producción y su susceptibilidad a la degradación enzimática y del pH aún limitan su implementación generalizada.
Los péptidos antimicrobianos (AMPs) son pequeñas proteínas (<10 kDa) compuestas por entre 12-50 aminoácidos, que exhiben una actividad antimicrobiana de amplio espectro contra bacterias, hongos, protozoos y virus.
Estos se han desarrollado como mecanismos de defensa del huésped frente a microorganismos y cumplen un papel importante en la inmunidad innata.
Los AMPs pueden exhibir diversos modos de acción, se degradan fácilmente en la naturaleza, presentan una acumulación reducida, mejoran la inmunidad del huésped, neutralizan la actividad de numerosos microorganismos y, además, parecen tener una baja frecuencia de resistencia.
Los AMPs pueden ser utilizados como promotores del crecimiento e inmunomoduladores.
Como promotores del crecimiento, la mayoría de los AMPs actúan alterando la membrana bacteriana a través de diversos mecanismos, tales como: electroporación, despolarización no lítica de la membrana, desestabilización de la membrana, formación de poros, adelgazamiento o engrosamiento de la membrana, y focalización en lípidos oxidados.
Sin embargo, algunos AMPs también pueden interactuar con objetivos intracelulares, inhibiendo la síntesis de las paredes celulares, proteínas y ácidos nucleicos, e interferir con el recambio metabólico bacteriano.
Los AMPs estabilizan la integridad de la barrera epitelial y estimulan la colonización del epitelio intestinal.
Algunos AMPs pueden inhibir la producción de citocinas proinflamatorias o modular las respuestas de células dendríticas (CD) y células T.
La sobreexposición de patógenos a los AMPs puede desarrollar cepas resistentes a los AMP mediante diversos mecanismos, como la alteración de las membranas bacterianas, la modificación del potencial iónico celular bacteriano y la producción de biopelículas.
Los bacteriófagos son virus que se replican mediante bacterias específicas. Dependiendo sus interacciones con las bacterias y su ciclo de vida, los fagos se pueden dividir en líticos (o virulentos) y lisogénicos.
Los bacteriófagos se clasifican en muchos órdenes y 15 familias.
La mayoría de los fagos (96%) pertenecen al orden Caudovirales, que corresponde a los fagos con cola. Este orden se divide a su vez en tres familias:
Siphoviridae (que incluye el 61% de los fagos con cola),
Myoviridae (25%), y Podoviridae (14%).
Las mutaciones en los lipopolisacáridos de la membrana pueden hacer que las bacterias se vuelvan resistentes a los fagos. Para evitar este problema, se recomienda administrar cócteles de fagos en lugar de fagos aislados.
Sólo se deben utilizar fagos líticos potentes con genomas bien caracterizados.
La resistencia a los antimicrobianos es un problema que debe ser vigilado de cerca, y se deben implementar estrategias de control, ya que afecta la sostenibilidad y rentabilidad del sistema de producción avícola.
Resistencia a los antimicrobianos en la cadena alimentaria avícola y nuevas estrategias de control bacteriano
DESCÁRGALO EN PDF

Oligoelemento Bis-Quelado
Un producto NOVUS
novusint.com/poultryminerals
SÓLO MINTREX® OLIGOELEMENTO BIS-QUELADO OFRECE LA ABSORCIÓN
PROACTIVA QUE NECESITAS PARA MAXIMIZAR LA NUTRICIÓN.
Nuestros oligoelementos orgánicos son los únicos minerales que han demostrado que pueden resistir el tránsito a través del tracto digestivo y llegar al lugar de absorción, ayudando así a un mayor enriquecimiento tisular.
Gracias a su alta biodisponibilidad, MINTREX® Oligoelemento Bis-Quelado ayuda a reducir la mortalidad y optimizar el crecimiento de los pollos de engorde para que tengan la integridad estructural que les permite mantenerse más saludables y ofrecer un mayor rendimiento desde el inicio hasta el final del ciclo productivo.
® y MINTREX son marcas registrada de Novus International, Inc. en los Estados Unidos y en otros países. ©2025 Novus International, Inc. Todos los derechos reservados.
Dra. Norma L. Calderón y Dr. Leopoldo H. Paasch
Facultad de Medicina Veterinaria y Zootecnia, UNAM
En la primera parte de este artículo se abordó la importancia de la avicultura familiar en zonas rurales y los desafíos sanitarios que enfrenta, especialmente por enfermedades virales como la Enfermedad de Marek y la Leucosis Linfoide.
Ambas presentan manifestaciones clínicas y lesiones anatomopatológicas similares, dificultando el diagnóstico diferencial y afectando la sanidad de las parvadas.
Esta segunda parte profundiza en los aspectos histopatológicos, diagnósticos, y en las estrategias de prevención y control.
El objetivo es brindar a los veterinarios rurales herramientas técnicas para proteger las aves criollas y asegurar la sostenibilidad de la avicultura familiar.


Las lesiones histológicas en la enfermedad de Marek se caracterizan por:
En los infiltrados se pueden observar células plasmáticas.
Clasificación de las lesiones en los nervios (según Payne y Biggs):

Infiltrados linfoides en diferentes órganos y tejidos, formados por:
Linfocitos pequeños y medianos

Linfoblastos

Células grandes redondas, llamadas células de Marek, con citoplasma basofílico y núcleo abierto con nucléolo prominente.

En los nervios periféricos:
Además de infiltrados linfoides, se observa degeneración y necrosis de las fibras de mielina.

Figura 6. Corte histológico de nervio. Tinción H.E. A degeneración waleriana con fragmentación y enrollamiento de las vainas de mielina. B infiltrado linfocitario leve. Enfermedad de Marek.

Figura 8. Corte histológico de nervio. Tinción H.E. Severa infiltración linfocitaria con marcado pleomorfismo celular. Enfermedad de Marek.
Lesión tipo A: Infiltración masiva de células linfoides en diferentes estados de maduración, desmielinización y proliferación de células de Schwann.
Lesión tipo B: Separación de fibras nerviosas por edema, infiltrado moderado de células linfoides, desmielinización y proliferación de células de Schwann.
Lesión tipo C: Edema e infiltración linfoide focal. (Figuras 6, 7, 8 y 9)

Figura 7. Corte histológico de nervio. Tinción H.E. A foco de infiltrado linfocitario con pleomorfismo celular. Las flechas indican focos de edema y desmielinización. Enfermedad de Marek.

Figura 9. Corte histológico de miocardio. Tinción H.E. Separación de las fibras cardiacas por abundante infiltrado intersticial de linfocitos pleomórficos que incluyen las llamadas células de Marek. Enfermedad de Marek.

Las lesiones microscópicas en la Leucosis linfoide, consisten en infiltrados homogéneos de células linfoblásticas.
Las neoplasias se originan en la bolsa de Fabricio, en los folículos, hay una transformación tumoral de los linfocitos B.
Esto ocurre alrededor de la sexta semana de edad. Se trata de grandes folículos tumorales muy prominentes que comprimen y desplazan a los folículos normales. (Figuras 10, 11, 12 y 13).

Figura 10. Corte histológico de la Bolsa de Fabricio. Tinción H.E. Dos folículos centrales con transformación de linfocitos neoplásicos. Los demás folículos están atrofiados. Leucosis linfoide.

Figura 12. Corte histológico de miocardio. Tinción H.E. Foco de infiltración con células neoplasicas predominantemente linfoblastos. Leucosis linfoide.

Figura 11. Corte histológico de la Bolsa de Fabricio. Tinción H.E. Folículo neoplasico con población uniforme de linfoblastos. Nótese la presencia de figuras mitóticas. Leucosis linfoide.

Figura 13. Corte histológico de hígado. Tinción H.E. Foco de infiltración neoplásica perivascular consistente en una población uniforme de linfoblastos. Leucosis linfoide.





Edad
Parálisis o paresia
Lesiones en nervios y ganglios nerviosos periféricos
Bolsa de Fabricio
Tumores en piel y músculo
Infiltración en nervios periféricos
Manguitos perivasculares en materia blanca y cerebelo
Infiltración en piel con patrón folicular y células linfoides


Enfermedad de Marek Leucosis linfoide
4 semanas de edad
Signos clínicos
Presentes
Vía de transmisión
Horizontal por caspa de la pluma
Lesiones macroscópicas
Presentes
16 semanas de edad

Ausentes
Horizontal, vertical y genética
Ausentes
Inicio hay atrofia. Tumores nodulares Tumores nodulares
Pueden estar presentes
Lesiones microscópicas
Presente
Ausentes
Ausente
Presente Ausente
Presente Ausente
Proliferación celular en bolsa de Fabricio Intersticial Intrafolicular
Citología de las células linfoides
Células maduras e inmaduras pleomórficas . Linfocitos T Linfocitos B inmaduros (linfoblastos)
Tabla 1. La tabla comparativa permite diferenciar de manera clara las características clínicas, macroscópicas y microscópicas entre la Enfermedad de Marek y la Leucosis Linfoide.
Cuando se trata de una salud intestinal óptima, el microbioma debe funcionar como una orquesta que toca en perfecta armonía. Al frente de esta orquesta está Symphiome™ , un biótico de precisión único y el primero en su clase. Su exclusivo modo de acción aumenta las funciones metabólicas intrínsecas de la microbiota de las aves, lo que permite la activación de rutas metabólicas beneficiosas, independientemente de la composición de la microbiota. Symphiome™ mejora la resiliencia al estrés entérico, mejora el bienestar y reduce las emisiones.
Si no nosotros, ¿quién? Si no ahora, ¿cuándo? Lo Hacemos posible






Historia clínica:
Es crucial saber si las aves han sido vacunadas contra la Enfermedad de Marek, cuál fue la vacuna utilizada y el calendario de vacunación.
Necropsia completa:
Debe incluir la inspección de los plexos nerviosos y los nervios periféricos.
Histopatología:
La histopatología es esencial para un diagnóstico preciso, especialmente en función del tipo de infiltración linfoide y su localización
Los infiltrados linfocitarios en los nervios son patognomónicos de la enfermedad.
Pruebas de diagnóstico:
Inmunohistoquímica y PCR son útiles para identificar la enfermedad.
Se utilizan técnicas moleculares, como la PCR cuantitativa, para detectar el genoma viral en tumores.
Pruebas serológicas:
Las pruebas serológicas incluyen:
Inmunofluorescencia
Inmunohistoquímica
ELISA
Prueba de la precipitina en agar
Virus neutralización.

Anteriormente, se resaltan los métodos clave para diagnosticar la Enfermedad de Marek, desde la historia clínica hasta las pruebas especializadas
Edad de detección:
La Leucosis linfoide no es observable en parvadas de pollo de engorde, ya que la detección de tumores se realiza generalmente a partir de las 16 semanas de edad.
Diferenciación con la Enfermedad de Marek:
Es importante enfatizar la ausencia de lesiones en los plexos nerviosos y nervios periféricos, ya que estas son patognomónicas de la Enfermedad de Marek.
Características histológicas:
En la Leucosis linfoide, los infiltrados de células tumorales son uniformes y están formados por linfoblastos.
En contraste, en la Enfermedad de Marek, los infiltrados linfoides son pleomórficos (presentan diferentes formas).
Pruebas para diagnóstico:
Se han descrito varias pruebas biológicas para la detección de Leucosis linfoide, incluyendo:
Criterios virológicos y serológicos para detectar el virus, antígenos virales y anticuerpos específicos.
Estas pruebas son útiles para asegurar la ausencia de infección en aves libres de patógenos y en reproductoras. También ayudan a garantizar que las vacunas estén libres de virus.
Limitaciones de las pruebas:
El valor diagnóstico de estas pruebas es limitado, ya que los virus oncogénicos en las aves frecuentemente producen infección sin inducir neoplasias.

Las medidas de bioseguridad que se emplean en la avicultura actual influyen en la prevención de todas las enfermedades infecciosas incluyendo la Enfermedad de Marek, sin embargo, la vacunación es imprescindible y debe realizarse al primer día de edad o a los 18 días in ovo.
Están disponibles comercialmente vacunas con los siguientes serotipos:
Serotipo 3 HVT: Cepa FC-126.
Serotipo 2: Cepas SB-1 y 301B/1
Serotipo 1: Cepa atenuada CVI-988 y HPRS-16.
También existen vacunas bivalentes como:
SB-1 (serotipo 2) + FC-126 (serotipo 3).
CVI-988 (serotipo 1) + HVT.
Y vacunas trivalentes como:
Serotipo 1 + serotipo 2 + serotipo 3.
Entre las vacunas recombinantes se encuentran:
HVT + gen viral de IBF + gen viral de LTI.
HVT + gen viral de IBF + gen viral de ENC.
Igualmente implementar todas las medidas de bioseguridad y de ser posible monitorear permanentemente las parvadas de reproductoras con las pruebas biológicas de detección viral, de antígenos virales y de anticuerpos específicos, para eliminar a las aves portadoras del virus o que presenten anticuerpos. No existe vacunación contra la Leucosis aviar.
La Enfermedad de Marek y la Leucosis
Linfoide son amenazas serias para la avicultura familiar. Su control exige diagnóstico preciso, bioseguridad estricta y vacunación (solo para Marek).
Es esencial, capacitar veterinarios rurales y proteger aves criollas para mantener la salud aviar, preservar la diversidad genética y asegurar la sostenibilidad de la producción en sistemas no tecnificados.

Importancia en la avicultura familiar y de traspatio de la Enfermedad de Marek y la Leucosis Linfoide- Parte II DESCÁRGALO EN PDF
Mireya López
Coordinadora técnico comercial de avicultura en Trouw Nutrition Sur y Centroamérica.

El sistema inmunitario es un sistema complejo de defensa que protege al organismo de injurias que podrían causar enfermedades. Comienza a desarrollarse durante la vida embrionaria.
Sin embargo, la inmunocompetencia tarda en conseguirse, por lo que los anticuerpos maternos juegan un papel muy importante en las primeras etapas de vida. Está presente en todos los tejidos, especialmente en intestino y pulmones.
El sistema inmunitario está conformado por diversos tipos de células y proteínas corporales especializadas y se divide en inmunidad innata y adaptativa, existiendo entre ellos muchos elementos comunes, a pesar de la distancia evolutiva.
Inmuno competencias
Inmunidad innata
Caída Inmunidad AC de la yema de huevo (IgG e IgA)
Caída inmunidad
0 Preinicio
Inmunidad adquirida
Inicio 21 Crecimiento 35 Finalizador 42 mm
Para mantener el correcto funcionamiento de la inmunidad, es importante conocer los factores que pueden afectarla.
En general, los entornos desfavorables inhiben las respuestas normales.
Entre los principales factores involucrados estarían el estrés, el estado nutricional, el aporte de nutrientes, inmunomoduladores, inmunoestimulantes, entre otros

El estrés por calor estimula el eje hipotálamo-hipófisis-suprarrenal con lo que se produce un incremento en los niveles de mediadores neuroendocrinos. Esto puede ocasionar una disminución del tamaño de los órganos inmunes, alterando su función, disminuyendo la población de células de defensa.
El estrés, ya sea causado por factores ambientales (altas o bajas temperaturas, hacinamiento) o por enfermedades, puede debilitar el sistema inmunitario.
Adicionalmente, aumenta la síntesis de ácidos grasos, la acumulación de grasa y el catabolismo proteico y puede causar inflamación del epitelio yeyunal, con disminución de la altura de las vellosidades y aumento de la permeabilidad a los microorganismos.
Por otra parte, altera el estado antioxidante del organismo, con lo que induce daño oxidativo mediante la producción excesiva de especies reactivas de oxígeno (ROS).
Estas pueden dañar las proteínas, los lípidos, ADN y otros componentes celulares. Para contrarrestar esta situación es necesario el uso de antioxidantes.
Para fortalecer el sistema inmunitario de las aves de corral, se requiere un enfoque multifacético, centrado en la nutrición, el entorno y las medidas preventivas.
Dentro de estas medidas guarda especial importancia:
Proporcionar una dieta equilibrada con aportes nutricionales adecuados,
Suministrar aditivos inmunomoduladores e inmunoestimulantes,
Crear un entorno libre de estrés, e
Implementar protocolos de bioseguridad.
Una nutrición adecuada mitiga la inmunosupresión asociada al estrés en las aves.
La nutrición afecta a la función inmunitaria mediante la modulación del desarrollo de los tejidos linfoides, la síntesis de inmunomoduladores, la producción de moco, la proliferación

En los últimos años, el uso de aditivos bioactivos se ha popularizado. Dentro de estas alternativas destacaremos algunas con efecto inmunoestimulante e inmunomodulador como:
Fitonutrientes (polifenoles y aceites esenciales), Polisacáridos, Minerales, y Ácidos orgánicos.
Buscando siempre que dichas alternativas también favorezcan a la microbiota intestinal.

Los oligoelementos esenciales, de alta biodisponibilidad, como el zinc (Zn), el cobre (Cu) y el selenio (Se), alivian el efecto perjudicial del estrés térmico y desempeñan un papel fundamental en la función inmunitaria normal y en las enzimas antioxidantes.

En general, en la mayoría de los ensayos de campo realizados, en condiciones de reto, con fuentes de hidroxicloruros como los minerales Selko ® Intellibond (Trouw Nutrition), los animales muestran un mayor rendimiento en comparación con aquellos cuya dieta contiene oligoelementos inorgánicos.
Los polifenoles de alta biodisponibilidad, como los presentes en el Selko ® AOmix (Trouw Nutrition), pueden neutralizar las especies reactivas de oxígeno (ROS) y aumentar la capacidad antioxidante del cuerpo. Como resultado se mejora la respuesta inmunitaria celular, así como los parámetros productivos.
son agentes que regulan la capacidad de respuesta de una o más poblaciones celulares inmunológicamente competentes.
Entre los más usados están los 1,3 y 1,6 betaglucanos conocidos como modificadores de la respuesta biológica debido a su efecto antiinflamatorio y su capacidad para activar el sistema inmunitario.
Prueba de ello lo constituyen los ensayos con productos como el Selko ® Fibosel (Trouw Nutrition) en donde se ha evidenciado un aumento de peso moderado en el bazo y la bolsa de Fabricio, así como la mayor producción del óxido de nítrico (NO) por parte de los macrófagos, el cual es un indicador químico de inflamación.
Los ácidos orgánicos pueden ser suministrados vía alimento o agua de bebida. Es Importante el uso de mezclas con ácidos orgánicos de lenta liberación o tamponados que logren alcanzar el área objetivo.
Al respecto, los ésteres de alquilo de ácidos grasos de cadena media son una excelente opción. En ensayos realizados con Selko ® Presan (Trouw Nutrition) se ha reportado un efecto positivo del C12 sobre la diversidad de la microbiota, así como sobre su capacidad de interferir en la acumulación de macrófagos productores de citoquinas.

Por otra parte, con el uso de ácidos orgánicos y sus sales en agua de bebida ha demostrado algunos beneficios directos sobre el sistema inmunológicos, como son los referidos para el ácido fórmico que puede inducir un aumento del número de linfocitos en el bazo y títulos de anticuerpos contra la enfermedad de Gumboro.
Todos estos beneficios se traducen en mejoras a nivel de los resultados zootécnicos.
son aquellos compuestos que sobreactivan el sistema inmune bajo la influencia de la exposición a patógenos o sustancias inmunoestimulantes. Dentro de este grupo los fitoquímicos juegan un papel preponderante.
Estos son compuestos bioactivos de origen vegetal que incluyen una amplia variedad de hierbas y especias, así como diversos aceites esenciales (timol, carvacrol, cinamaldehído, aceites esenciales de clavo, cilantro, anís estrellado, jengibre, ajo, romero, cúrcuma, albahaca, alcaravea, limón y salvia), que se han utilizado individualmente o en mezclas para mejorar la salud y el rendimiento animal.

Reforzando el sistema inmune de nuestras aves DESCÁRGALO EN PDF
Su efectividad ha sido comprobada en algunos ensayos realizados, tanto in vitro como in vivo con productos como el Selko ® Fytera Perform (aceites esenciales de canela, clavo y orégano), diseñado por Trouw Nutrition.
En ensayos in vivo se encontró una disminución de la respuesta inflamatoria (reducción de calprotectina como la ovotransferrina), una mejora en la morfología de la capa mucosa intestinal y un incremento de la permeabilidad intestinal. Histológicamente, se observó una mayor relación vellosidades-criptas lo que indica una mejor integridad intestinal y capacidad de absorción.
De acuerdo con lo antes expuesto, podemos concluir que el sistema inmunitario es uno de los sistemas más vulnerables de nuestros animales. Distintos factores a los que el ave está expuesta, de manera rutinaria, lo pueden afectar negativamente como el estrés, el estado nutricional, el aporte de nutrientes, etc.
Esto puede traer consecuencias negativas para el desempeño de los animales, por lo que cualquier esfuerzo que se haga para fortalecerlo por medio de nutrición puede garantizar el éxito de las explotaciones avícolas.
Referencias bajo consulta al autor


La producción intensiva de aves de larga vida constituye un modelo eficiente para maximizar el potencial productivo y reproductivo, garantizando el suministro de alimentos inocuos y nutritivos en grandes cantidades, en respuesta a las crecientes exigencias del mercado.
El sector avícola se consolida como el de mayor crecimiento a nivel global, impulsado por la creciente demanda de alimentos seguros, accesibles y de alta calidad nutricional.

La carne de pollo y los huevos se destacan como fuentes de proteína de alto valor biológico y nutrientes esenciales, fundamentales en la alimentación de una población en constante expansión.
Garantizar su disponibilidad e inocuidad representa un desafío estratégico para la salud pública y la sostenibilidad del sistema productivo, desde la granja hasta la mesa.
Uno de los pilares claves para lograr una producción avícola eficiente es el control sanitario, basado en estrategias integradas que incluyen programas de vacunación, prácticas de manejo adecuadas y estrictas medidas de bioseguridad.

El éxito de los programas de vacunación depende de múltiples factores, no solo depende de la formulación y manejo de la vacuna, sino que también de la capacidad de las aves para generar una respuesta inmune sólida tras la inmunización.
Diversos factores externos pueden interferir en el nivel de inmunidad protector alcanzado, comprometiendo la eficacia de las vacunas.
Las aves en producción están expuestas a diversos factores estresantes:
tanto ambientales (temperatura, densidad, ventilación),
nutricionales (desequilibrios, presencia de micotoxinas)
como sanitarios (saneamiento, agentes infecciosos), que pueden afectar el equilibrio metabólico.
Como consecuencia del incremento metabólico del organismo, se genera de forma excesiva especies reactivas de oxígeno (ROS). Cuando estas superan la capacidad antioxidante del organismo, se desencadena un estrés oxidativo, que provoca daño celular y compromete las funciones vitales, como la respuesta inmune, la integridad intestinal y la salud hepática.
En este contexto, contar con el apoyo de estrategias antioxidantes es clave para mitigar los efectos del estrés oxidativo en etapas críticas de producción, optimizar la recuperación y así mejorar la salud y el rendimiento.
DI HEPTARINE S® es un aditivo natural formulado con Silimarina, un compuesto presente en las semillas del Cardo Mariano (“Silybum Marianum”), conocido por su efecto hepatoprotector.
Sus principales acciones son:
Antioxidante: neutraliza radicales libres, protegiendo y estabilizando las membranas celulares.
Antiinflamatoria: tiene la capacidad de inhibir a la enzima 5-lipooxigensa, bloqueando la cascada del ácido araquidónico y reduciendo la liberación de citoquinas proinflamatorias.
Regeneradora celular: Estimula la ARN polimerasa, favoreciendo la síntesis de proteínas y enzimas hepáticas claves para el metabolismo.

En este artículo se abordará el rol de DI HEPTARINE S® como modulador fisiológico e inmunológico en aves sometidas a una alta demanda metabólica.
A partir de una revisión de mecanismos fisiológicos y evidencia experimental, se analizarán los efectos sobre la reducción del estrés oxidativo, lo que favorece una mejor recuperación de las aves y una respuesta inmunitaria eficaz a la vacunación.
Se presentan resultados de ensayos realizados en diferentes establecimientos productivos que demuestran mejoras serológicas frente a las vacunaciones contra enfermedades clave como Newcastle (ND) y Bronquitis Infecciosa (IBV).

Evaluar el efecto del DI HEPTARINE S® sobre la respuesta inmune a los programas de vacunación en aves de larga vida.
Evaluar la respuesta inmune humoral mediante los niveles de anticuerpos generada por los programas de vacunación contra la Enfermedad de Newcastle.
Lugar del ensayo
Granja ubicada en Tepatitlán de Morelos, Jalisco.
Caseta 1 DI HEPTARINE S®
Se trabajó con dos grupos de pollitas de reemplazo:
Caseta 1 (C1): grupo tratado con DI HEPTARINE S®, durante 7 días en la semana 3, que luego continuaron con su esquema de vacunación de ND.
Caseta 2 (C2): grupo control.
Programa de vacunación contra la Enfermedad de Newcastle (ND)

Semana 3
Caseta 2 Control
Semana 6 Semana 8
2do 1er muestreo



Se tomaron 15 muestras de suero por caseta en las semanas 3, 6 y 8 de edad, que fueron identificadas y enviadas al laboratorio refrigeradas para la siguiente prueba:
Prueba de Inhibición de la Hemaglutinación (HI) para ND.
Respuesta inmunológica frente a ND (HI)
HI:Newcastle 14,00






Gráfico 1. Resultados correspondientes de HI para ND - Comparación entre casetas
La respuesta inmune humoral frente a Newcastle mostró diferencias marcadas entre los grupos evaluados:
En el primer muestreo (semana 3), las aves del grupo tratado con DI HEPTARINE S® (caseta 1) presentaron títulos protectivos, siendo un 37,4% superiores en nivel de inmunidad al grupo control (caseta 2), el cual no alcanzó el umbral protectivo.
A partir de la semana 6, ambos grupos mostraron seroconversión protectiva, sin embargo, el grupo tratado con DI HEPTARINE S® presentó una inmunidad residual superior, con un 25,6% más en la persistencia de los títulos en comparación al grupo


Estos resultados reflejan que el uso de DI HEPTARINE S® en aves jóvenes contribuye a una seroconversión más temprana y efectiva frente a ND, lo que representa una ventaja clave en programas de vacunación.





Objetivos
Evaluar la respuesta inmune humoral mediante los niveles de anticuerpos generada por los programas de vacunación contra la Enfermedad de Newcastle (ND) y Bronquitis infecciosa (IBV) en aves reproductoras pesadas.
Lugar del ensayo
Granja ubicada en Guadalajara, Jalisco, México.
experimental

Grupo 1 (Control): recibió el manejo nutricional y sanitario estándar de la empresa, sin adición de tratamientos complementarios.
Grupo 2 (Tratado - DI HEPTARINE S®): además del manejo estándar, recibió DI HEPTARINE S® solución en el agua de bebida como tratamiento complementario, a razón de 500 ml por cada 1000 Litros por 10 días desde la semana 64.
Se evaluaron un total de 27.500 gallinas reproductoras y 2.880 machos de la estirpe Ross, con 65 semanas de edad que regresaban de la pelecha, divididos en dos grupos experimentales de aproximadamente 15.000 aves cada uno. Se revacunaron en la semana 65 con una vacuna emulsionada de ND, IBV y gumboro.
Se realizaron pruebas serológicas a ambos grupos experimentales mediante ELISA para detección de anticuerpos frente a Bronquitis Infecciosa (IBV) y Prueba de Inhibición de la Hemaglutinación (HI) para la Enfermedad de Newcastle (ND).

Grupo 1 Control
15.000 aves
Semana 62
15.000 aves Grupo 2 DI HEPTARINE S®
HEPTARINE S® 10 días Grupo 2
Revacunación contra Newcastle (ND) + Bronquitis Infecciosa (IBV)
Semana 64 Semana 65 Semana 67 Semana71

En cada punto de muestreo, se extrajo sangre de 20 aves sanas seleccionadas al azar por grupo.
*La toma de muestra basal fue para los dos grupos de aves en la semana 62, las cuales estaban regresando de la pelecha.




Gráfico 2. Resultados correspondientes de HI para
En la semana 67, el grupo tratado con DI HEPTARINE S® (grupo 2) mostró una mejora inmunológica del 9,75% en los títulos de anticuerpos frente a Newcastle, comparado con el grupo control (grupo 1). En la semana 71, la mejora fue del 3,92%, también a favor del grupo tratado.



En la semana 67, el grupo tratado con DI HEPTARINE S® (Grupo 2) presentó una mejora inmunológica del 4,27% respecto al grupo control (Grupo 1). En la semana 71, la mejora fue del 2,51% en el grupo tratado con DI HEPTARINE S®(Grupo 2).
ELISA: Bronquitis Infecciosa



Gráfico3. Resultados correspondientes de ELISA para IBV




Los resultados serológicos obtenidos en aves reproductoras indican que el uso de DI HEPTARINE S® contribuye a una mejor respuesta inmunológica frente a ND e IBV, evidenciada por mayores títulos de anticuerpos en las semanas posteriores a la vacunación en aves sometidas a alta demanda metabólica.
Los ensayos realizados en aves de larga vida – tanto reproductoras como ponedoras comerciales – confirman el valor de DI HEPTARINE S® como una herramienta funcional en programas de soporte inmunológico, prevención de estrés metabólico y optimización de parámetros productivos.
Desde el punto de vista inmunológico, se observaron mejoras significativas en la respuesta inmune frente a las vacunaciones para Newcastle (ND) y Bronquitis Infecciosa (IBV).
En todos los ensayos, las aves tratadas con DI HEPTARINE S® mostraron títulos de anticuerpos más altos y sostenidos, lo que sugiere una mayor eficiencia en la seroconversión posterior a la vacunación.
Esta ventaja inmunológica es especialmente relevante en reproductoras de edad avanzada (65–71 semanas) y en lotes sometidos a condiciones de alta demanda metabólica o situaciones de estrés, donde la respuesta inmune suele verse comprometida.
Desde el enfoque productivo, ensayos realizados con DI HEPTARINE S® evidenciaron mejoras en la producción y calidad del huevo, así como una reducción en la mortalidad. También se observó una mayor estabilidad productiva, incluso bajo condiciones de estrés calórico, lo que refleja su impacto positivo sobre el bienestar y el rendimiento de las aves.
El uso estratégico de DI HEPTARINE S® se posiciona como una herramienta eficaz para minimizar los efectos negativos del estrés oxidativo y los desafíos en sistemas de producción intensiva,
permitiendo que las aves de alta exigencia metabólica desarrollen una mejor respuesta inmune a la vacunación, mejorando así su desempeño sanitario y productivo.

Referencias bajo consulta al autor
Efecto del DI HEPTARINE S® sobre la respuesta inmune a los programas de vacunación en aves de larga vida DESCÁRGALO EN PDF



Sergio Álvarez Jiménez - MVZ EPA
Equipo Técnico Sanfer

Introducción
La Coriza Infecciosa Aviar (CIA) es una enfermedad respiratoria bacteriana de gran impacto económico en la avicultura comercial. A. paragallinarum tiene distribución a nivel mundial.







Algunos países como China, Tailandia, Taiwán, Estados Unidos, México, Alemania y Sudáfrica han reportado la presencia de las tres serovariedades.
Australia y Japón, reportan sólo la presencia de los serovares A y C, pero no del serovar B.


Esta enfermedad es causada por la bacteria Avibacterium paragallinarum (anteriormente conocida como Haemophilus paragallinarum), se caracteriza por alta morbilidad y el impacto negativo en la productividad avícola.

Los signos clínicos observados son secreción nasal, hinchazón facial y una disminución en la producción de huevos. Dado que no existe una cura definitiva, el control de la enfermedad depende de la aplicación estratégica de medidas preventivas como la bioseguridad estricta (limpieza y desinfección profunda de unidades de producción con historial de enfermedad) y la bacterinización de las parvadas.
Avibacterium paragallinarum es un importante patógeno aviar a nivel mundial que produce la CIA, una enfermedad aguda y altamente contagiosa que afecta el tracto respiratorio superior de las aves. Las cepas bacterianas se clasifican en tres serogrupos A, B y C de acuerdo al esquema de Page, los cuales a su vez se reconocen nueve serovariedades A-1, A2, A3, A-4, B-1, C-1, C2, C3 y C-4 mediante el esquema de Kume modificado por Blackall.
Es un cocobacilo Gram-, dependiente del factor V de crecimiento (NAD) para su crecimiento, aunque en México se ha reportado el aislamiento de Avibacterium paragallinarum, serovariedad C-1, independiente del factor V de crecimiento.
Este microorganismo se inactiva fácilmente fuera del hospedero.
La virulencia asociada a A. paragallinarum se refiere al grado de patogenicidad de la bacteria asociado a la capacidad de invadir, colonizar y multiplicarse en su hospedero a través de varias herramientas como la cápsula y sustancias tóxicas.
Particularmente para esta bacteria, la hemaglutinina (HA) posee una gran importancia en la inmunogenicidad y patogenicidad. Además de la hemaglutinina, la cápsula es otro factor importante en la virulencia de la bacteria; algunos estudios han demostrado que las bacterias encapsuladas son más virulentas que las no encapsuladas.
La patogenicidad de A. paragallinarum puede ser resumida por el siguiente mecanismo:
1 2 3
Adherencia a la mucosa ciliar del tracto respiratorio superior.

Los signos respiratorios pueden permanecer por dos o tres semanas. Sin embargo, cuando se asocia con otros agentes complicantes como Micoplasma, Bronquitis Infecciosa Aviar o condiciones ambientales deficientes en las casetas, la infección se puede presentar por un período más largo (crónica), el cual se caracteriza por un mal olor percibido en el ambiente.
Los antígenos capsulares y la hemaglutinina juegan un papel importante en la colonización.
Sustancias tóxicas que se relacionen con el microorganismo durante la proliferación; todos son importantes en el desarrollo de los signos clínicos. Con la inmunosupresión, alcanza diferentes órganos produciendo lesiones.
Las aves infectadas presentan inflamación de los senos paranasales y cara, estornudos, conjuntivitis, con algunas adherencias en los párpados, presencia de exudado en ojos y narinas, y en algunas ocasiones la enfermedad puede difundirse a las vías aéreas inferiores como los pulmones y sacos aéreos. La agresividad de los signos clínicos puede variar de forma importante entre parvadas.
La CIA es transmitida a través de aerosoles de aves infectadas o por el consumo de agua o alimento contaminado con estos aerosoles, de tal manera que, la transmisión de esta enfermedad puede ser por medio de contacto directo con aves enfermas, aves con enfermedad crónica, por medio de aves portadoras asintomáticas o por contacto con fómites (instalaciones mal lavadas y desinfectadas).
Las aves de todas las edades son susceptibles; sin embargo, la susceptibilidad aumenta con la edad. Las aves que se recuperan de la enfermedad se mantienen como portadoras asintomáticas de por vida. La bacteria no se transmite de forma vertical por medio de huevo incubable.

Es fundamentan el establecer una estricta bioseguridad y adecuados calendarios de bacterinización, estas son las medidas más importantes para la prevención y control de la CIA. Además de la bacterinización, es importante la selección de un adecuado agente antimicrobiano para el tratamiento y control de la CIA.
La eficacia de las bacterinas contra Coriza Infecciosa se evalúa por medio de la respuesta serológica y por las pruebas de potencia. Las bacterinas inactivadas contra Coriza Infecciosa pueden despertar una respuesta humoral dirigidos a la hemaglutinina.
El impacto económico es significativamente alto, asociado principalmente a disminución en la producción de huevos de entre el 10% y el 40%, lo que afecta gravemente a las granjas comerciales.
Esta enfermedad se presenta de forma aguda y se difunde rápidamente, con una morbilidad que puede alcanzar entre un 60%-80% de la parvada susceptible. La mortalidad puede tener un rango que va de 1% a 15% y tiende a incrementar cuando se complica con otros agentes patógenos.
El antígeno contenido en las bacterinas inactivadas contra Coriza Infecciosa Aviar, pueden ser reconocidas por los receptores de las células B y de las células T, cuyo mecanismo incluye la activación de varios grupos de células como APC, MHC, CD4 y CD8.
Las aves que son inoculadas con un biológico inactivado de Coriza Infecciosa son capaces de generar una respuesta inmune específica dos semanas posteriores a la bacterinización inicial. Se ha reportado que, la aplicación de dos inmunizaciones provee protección más allá de las 56 semanas postinmunización con detección de altos niveles de anticuerpos.
En aves jóvenes A. paragallinarum, causa diarrea, disminución en los consumos de agua y alimento, así como baja conversión alimenticia que desencadena en retraso en el desarrollo de las aves afectadas.
A. paragallinarum puede participar en la formación de complejos respiratorios que conducen a signos clínicos severos, incrementando la mortalidad y el impacto económico negativo.
La combinación de esta bacteria con otras como:
Mycoplasma gallisepticum,
Sthaphylococcus aureus,
Ornitobacterium rinotracheale,
Salmonella enteritidis,
Salmonella typhimurium,
Pasteurella multocida,
Escherichia coli,
Especies de Proteus sp.,
Pueden originar cuadros complicados de Coriza Infecciosa.
En esta revisión, se aborda y se hace referencia a la importancia de esta enfermedad, el agente causal y su impacto económico para la avicultura, esto es impórtate tomarlo en cuenta en el diseño de programas de inmunización eficaces, acorde a la prevalencia de la enfermedad en las diferentes zonas geográficas.
En caso de un brote es muy importante la tipificación de la cepa, para conocer la serovariedad y de ser necesario hacer modificaciones o ajustes en los calendarios de vacunación.

La bacterinización contra Coriza Infecciosa Aviar es la mejor herramienta para la prevención de esta enfermedad, acompañada de rigurosas y bien instrumentadas medidas de bioseguridad.
Es importante que una vez se ha realizado la bacterinización, se evalué su desempeño inmunogénico a través de seguimientos serológicos.
Referencias bajo consulta al autor
Coriza Infecciosa Aviar: Una amenaza controlable DESCÁRGALO EN PDF


Carlos J. Cuello O. Equipo Técnico de Huvepharma
En los actuales sistemas intensivos de producción, las aves pueden verse afectadas por diversas enfermedades que ocasionan grandes pérdidas económicas, entre ellas se destacan:
coccidiosis
salmonelosis
histomoniasis
y las contaminaciones fúngicas en cosechas utilizadas en nutrición animal, pero una de las más costosas sin duda es la producida a nivel intestinal por Clostridium perfringens y sus toxinas.



La enteritis necrótica representa una de las enfermedades más graves para los productores de aves. Se estima que genera pérdidas de hasta 2.000 millones de dólares anuales en la industria avícola mundial (Timbermont et al., 2011).
La mortalidad por enteritis necrótica puede variar entre 1% y 50%, según la gravedad. Los síntomas incluyen depresión severa, diarrea, deshidratación, reducción en el consumo de alimento y letargo (Lee et al., 2011).
El estrés térmico, la vacunación, la alta densidad poblacional y alteraciones en la microflora intestinal favorecen el crecimiento de Clostridios. El nervio vago también se activa, afectando la motilidad intestinal (Wang et al., 2010).
Los lantobióticos son péptidos antimicrobianos producidos por bacterias Gram-positivas. Tienen un doble mecanismo de acción:
Formación de poros en bacterias diana, debilitando su membrana.
Inhibición de la biosíntesis de la pared celular.
Un ejemplo de lantobiótico es la lichenicidina, producida por la bacteria probiótica Bacillus licheniformis, que tiene la capacidad de inhibir efectivamente a Clostridium perfringens.

En este aspecto, desde hace décadas se han utilizados antibióticos como promotores de crecimiento para mantener controladas las poblaciones de
Los probióticos conteniendo bacterias con la capacidad de esporular (Genero Bacillus), tienen ciertas ventajas competitivas frente a los que contienen bacterias en estado vegetativo, por ejemplo, su capacidad para:
Soportar procesos industriales como la peletización del alimento.


Ser combinadas en la dieta o en el agua de bebida con productos como antibióticos, vacunas, anticoccidiales, ácidos orgánicos o aceites esenciales con actividad bactericida.

Ensayos de campo realizados mostraron que aves alimentadas con Bacillus licheniformis productor de lichenicidina presentaron mejor ganancia de peso y menor mortalidad. Su acción se debe a la exclusión competitiva y al antagonismo directo hacia C. perfringens (Pascual et al., 1999; Ibnou-Zekri et al., 2002).
En un estudio con 480 aves Ross 308 desafiadas con C. perfringens por inoculación oral a los días 18, 19 y 20, repartidas en cuatro grupos de tratamiento:
Control negativo (sin infección ni aditivos)
Control positivo (infectados con C. perfringens)
Grupo infectado + antibiótico (bacitracina metileno disalicilato)
Grupo infectado + Bacillus licheniformis (1 × 10⁹ UFC/kg)

menos profundas en el grupo suplementado con el probiótico, lo que indica una mejor absorción de nutrientes y menor inflamación. Las lesiones intestinales fueron significativamente menores en los grupos tratados (DFM y antibiótico) frente al grupo infectado.
En cuanto al análisis de microbiota intestinal, se observó una reducción significativa de Clostridium perfringens y un aumento de Lactobacillus spp en el grupo tratado con probiótico, lo cual indica un ambiente intestinal más saludable.

Las aves fueron evaluadas para cuatro variables:
Ganancia de peso
Conversión alimenticia
Morfología intestinal (altura de vellosidades, profundidad de criptas)
y Lesiones intestinales
El grupo tratado con el probiótico mostró una mejor ganancia de peso y conversión alimentaria y equiparable al grupo tratado con antibiótico, mostrando que puede ser una alternativa eficaz.
La enteritis necrótica, aunque a veces subdiagnosticada, tiene consecuencias económicas graves.
B-Act®, el probiótico producido por la compañía Huvepharma, ha demostrado ser eficaz en su prevención, representando una alternativa sostenible a los antibióticos y una solución confiable para una avicultura responsable y segura para el consumidor.
B-Act® Probiótico a base de Bacillus licheniformis que previene el impacto negativo de Clostridium perfringens DESCÁRGALO EN PDF

Equipo Técnico de Cobb-Vantress
Profesional con más de 25 años de experiencia en el mercado avícola asume la atención técnica a clientes en siete países de la región.
Cobb-Vantress, la casa genética avícola en operación más antigua del mundo, anuncia la llegada de Carlos Solorzano al equipo de Servicio Técnico LatCan. Con más de 25 años de experiencia en el mercado avícola, Solorzano asume el cargo de Gerente de Servicio Técnico para América Central, siendo responsable de las visitas técnicas a los clientes, capacitaciones y apoyo al departamento comercial.
Graduado en Zootecnia por la Universidad de San Carlos de Guatemala, el nuevo gerente también posee posgrado en Desarrollo y Evaluación de Proyectos, así como maestría en Investigación Científica por la Universidad Rural de Guatemala. Antes de unirse a Cobb, desarrolló una carrera de más de dos décadas en CMI (Corporación Multi Inversiones), donde actuó como Supervisor de Granjas y Gerente de Producción.

En su nueva función, Solorzano será responsable por el soporte técnico a los clientes de Cobb en siete países de América Central: El Salvador, Guatemala, Honduras, Nicaragua, Costa Rica, Panamá y Surinam. Su actuación incluirá visitas técnicas de campo, apoyo a la gestión de producción, capacitación de equipos locales y entrenamientos sobre buenas prácticas productivas.
“Mi principal misión es ofrecer a la industria un soporte técnico calificado, que contribuya a decisiones más acertadas y eficientes, con impacto directo en la rentabilidad de los negocios”, destaca Carlos Solorzano.
Cobb-Vantress anuncia a Carlos Solorzano como Gerente de Servicio Técnico para América Central DESCÁRGALO EN PDF


Este 2025, Grupo Disatyr celebra 40 años de trayectoria como socio estratégico de la industria alimentaria en Centroamérica.
Fundada en Julio de 1985 en San Pedro Sula, Honduras, por el Arq. José Bismark Tapia, la empresa nace con la visión de ofrecer soluciones integrales para el sector alimentario.
Cuatro décadas después, esa visión sigue firme, ahora consolidada con una sólida presencia en Guatemala, El Salvador, Honduras, Nicaragua, Costa Rica y Panamá.



Desde sus inicios, han atendido de manera especializada a los principales sectores agroindustriales: avicultura, acuicultura, porcicultura y ganadería, cubriendo desde las primeras etapas de producción hasta los procesos avanzados de transformación de alimentos.
Gracias a la especialización y enfoque por división de nuestro equipo, ha logrado brindar un soporte técnico y comercial altamente efectivo, permitiéndoles crecer junto a sus clientes y ser parte de la evolución del sector alimentario en la región.
Desde el inicio de sus operaciones, Grupo Disatyr identificó la necesidad de que empresas líderes a nivel mundial contarán con un aliado local confiable, capaz de brindar atención cercana, soporte técnico y seguimiento continuo a los clientes en la región.
En las últimas cuatro décadas, han tenido el privilegio de representar y seguir trabajando de la mano de más de 38 compañías internacionales de prestigio, integrando así un portafolio sólido y altamente especializado para sus clientes.
Inician operaciones en 1985, vendiendo equipos avícolas Big Dutchman en Honduras, una de las empresas más reconocidas a nivel mundial para equipos de producción de alta calidad y soluciones alimentarias de Novatec Pagani.


Con el paso de los años, amplían su alcance a otras áreas estratégicas y otros países, considerando la integración vertical de muchos de sus clientes.
En procesamiento y envasado, cuentan con el respaldo de marcas líderes como Magurit, Laska, Mainali, Günther, Marelec, Kerres, Poly-Clip, Ulma Packaging y Kuhl las cuales les permiten ofrecer tecnología de la más alta calidad.
En el área de Salud Animal, colaboran con empresas de prestigio como Cenavisa, especializada en productos veterinarias para múltiples especies.
En nutrición animal, trabajan con aliados como Igusol, expertos en brindar soluciones naturales y novedosas en el ámbito del buen desarrollo y bienestar animal.



Su expansión en Centroamérica inicia en 1990 con la apertura de oficinas en Nicaragua. Le siguieron El Salvador (1991), Guatemala (1995), Costa Rica (2009) y finalmente Panamá en el 2018.
En todos estos países se opera con oficinas y equipos de ventas y servicio técnico locales, lo cual les permite asegurar un acompañamiento cercano, ágil y efectivo a sus clientes.
Combinan conocimiento técnico, presencial local y respaldo internacional, lo cual los posiciona como el único proveedor en la región que ofrece soluciones integrales para toda la cadena de producción alimentaria.
Además de su equipo comercial, cuentan con un equipo técnico especializado por país, enfocado en brindar soporte postventa eficiente, capacitación práctica y asesoría en la implementación de nuevas tecnologías.
Celebrar estos 40 años no solo es motivo de orgullo, sino también una oportunidad para renovar su compromiso con la innovación, la excelencia y el servicio para el desarrollo de la industria alimentaria regional.
Grupo Disatyr: 40 años al servicio de la Industria Alimentaria Centroamericana
La oferta de Grupo Disatyr se organiza en cuatro divisiones comerciales especializadas, respaldas por un equipo de servicio técnico postventa altamente capacitado:
Nutrición Animal: Aditivos e ingredientes funcionales para plantas de alimentos balanceados.
Salud Animal: Soluciones veterinarias, desparasitantes, antibióticos, vitaminas y biológicos.
Equipo de Producción: Tecnología para plantas de alimentos, manejo de granos y equipos de incubación y para granjas de producción viva.
Equipos de Procesos y Envasado: Equipos para procesos primarios y secundarios de alimentos, sistemas de empaque, consumibles y automatización industrial.
Esta estructura de equipos de trabajo por área de especialización les permite responder de forma efectiva a los desafíos técnicos y productivos de sus clientes, asegurando un servicio completo desde el inicio del ciclo productivo hasta la etapa final de procesamiento y valor agregado.
Grupo Disatyr continúa trabajando con el mismo enfoque que los ha guiado desde 1985: ser el aliado confiable que les ayuda a transformar los retos del sector en oportunidades de crecimiento e innovación.



En el corazón de Paraguay, una empresa avícola ha logrado algo inusual: unir productividad, innovación y sostenibilidad bajo una misma visión. Se trata de Las Tacuaras S.A. – Nutrihuevos, liderada por Gustavo Koo, cuyo compromiso con el desarrollo sostenible va mucho más allá del discurso.
Con una planta de producción considerada entre las más modernas del Mercosur y un modelo empresarial centrado en el impacto social y ambiental, Nutrihuevos ha convertido la sostenibilidad en el eje estructural de su negocio.




En esta entrevista, Koo comparte el proceso de transformación que llevó a la compañía de la filantropía a una estrategia sostenible integral, abordando temas como innovación tecnológica, economía circular, cultura organizacional y desafíos de mercado. Una mirada honesta y profunda sobre cómo una empresa paraguaya se posiciona como referente regional en sostenibilidad empresarial.

¿Cuál fue el momento clave en que pasaron de acciones sociales a un enfoque sostenible estructurado?
Hace más de 15 años comenzamos con acciones filantrópicas sin comprender del todo qué significaba sostenibilidad.
Una vez pagada las deudas contraídas para la construcción de la nueva planta, mi padre tenía el deseo de retribuir al país. Así, destinamos 100.000 dólares anuales a proyectos sociales, principalmente en mejoras de las escuelas públicas donde asistían los hijos de nuestros colaboradores.
Participamos de la primera capacitación de Responsabilidad Social Empresarial organizado por la ADEC donde aprendimos sobre los 7 ejes. Pasamos de la filantropía a la RSE, incorporando los 7 ejes y rediseñando todas nuestras acciones desde dentro de la empresa (gobernanza, público interno, derechos humanos, medio ambiente) hacia afuera (público externo, proveedores, comunidad).
Pero hace unos años, en el proceso de maduración en este camino, entendimos que la sostenibilidad no podía limitarse al corazón de la empresa, sino debía integrarse al centro del negocio. Estábamos destinando cerca del 3% de la facturación anual en nuestro modelo de sostenibilidad sin que esto impacte en el negocio en sí. Contratamos una consultora internacional para rediseñar todo nuestro modelo, del cual nacen tres ejes estratégicos vinculados al plan estratégico del negocio: Prosperidad, Nutrición y Medio Ambiente.
¿Cómo fue ese cambio cultural interno en la empresa?
Fue un proceso largo. Aunque comunicábamos bien hacia afuera, internamente muchos no estaban enterados de todas las acciones de la empresa. Si nuestros colaboradores no eran nuestros primeros embajadores, nuestra comunicación estaba fallando.
Convertimos el lanzamiento del Reporte de Sostenibilidad en uno de los eventos más importantes para nuestros colaboradores.
Una vez que mejoramos nuestra comunicación para el público interno, se fortalecieron varios factores como el clima organizacional, la retención de talentos y la imagen de la empresa.
“Nunca trabajé en una empresa así”
Esto fortaleció nuestra cultura y nos volvió muy atractivos para la retención e incorporación de nuevos talentos.
Hoy, desde el programa de inducción, cada nuevo colaborador conoce nuestra visión de sostenibilidad con lenguaje claro y herramientas visuales.
¿Qué indicadores utilizan para medir el impacto?
Nos basamos en los Objetivos de Desarrollo Sostenible (ODS): respondemos a 14 de los 17 ODS. Cada acción tiene responsables y metas bien definidas. También aplicamos el análisis de materialidad, donde identificamos riesgos y prioridades que responden a las expectativas de nuestros grupos de interés.
Nuestros Reportes anuales de Sostenibilidad siguen los estándares del GRI (Global Reporting Initiative) y son compartidos con el Pacto Global y a todos nuestros grupos de interés.
A nivel ambiental, medimos nuestra huella de carbono e hídrica. Tenemos como objetivo ser una empresa carbono neutral para el 2030. Anualmente reducimos nuestra huella hídrica y el año pasado logramos una reducción significativa del 38%.
Además, gestionamos el 83% de nuestros residuos.
¿Qué papel juega la innovación tecnológica?
La innovación tecnológica es clave y constante. Continuamente invertimos en la mejor tecnología disponible en el mercado para todos los procesos y de esa manera, ser más eficientes y rentables.
Además, certificamos la inocuidad de nuestros productos con la ISO22000 y nuestros procesos de la granja a la mesa con la ISO9000, asegurando que la calidad e innovación aporten valor real.



Un recuento de huevos por cinta muy preciso y compatible con todo tipo de cintas, huevos y granjas
Menos cáscaras dañadas
Ahorra tiempo y costes de producción
Menos complejidad en el proceso de recogida



Con las soluciones de gestión del flujo de huevos de Hotraco Agri conseguirá que cada paso de su proceso de recogida de huevos sea lo más eficiente, consistente y automatizado posible. Descubra cómo nuestras soluciones reducen los costes de mano de obra, minimizan los huevos rotos y mejoran la productividad.


Conozca Hotraco y descúbralo todo sobre el control del flujo de huevos adaptativo





Estamos incorporando la inteligencia artificial en diferentes procesos para seguir estando en la vanguardia de la innovación.
No buscamos innovar por innovar, sino para mantenernos eficientes y sostenibles.
¿Qué prácticas de economía circular aplican?
La economía circular es parte central de nuestra estrategia. Un ejemplo es la producción de las bandejas de huevos, donde reciclamos diariamente 6.000 kilos de residuos comprados de recicladores y lo transformamos en 50.000 bandejas de cartón para huevos.
Además, gestionan 150 toneladas diarias de estiércol, que transforman en fertilizante seco mediante compostaje con tecnología japonesa, cerrando así el ciclo productivo y generando valor a partir de residuos.
Este producto representa una segunda unidad de negocio en expansión y marca un hito, ya que somos la primera empresa en Paraguay que convierte el estiércol de gallina en un fertilizante orgánico mineral para la agricultura de precisión.
¿Cuál es la capacidad actual del complejo Don Antonio y qué desafíos enfrentan?
Tenemos una capacidad de 1,6 millones de aves en fase de producción y 400.000 aves en cría/recría. En esta planta hemos alcanzado el límite de crecimiento y por razones de bioseguridad, la expansión se dará en una nueva planta avícola.
Proyectamos una nueva granja en un predio más aislado, cerca de zonas agrícolas, lo que permitirá crecer sin comprometer la sanidad del plantel y reforzar nuestra resiliencia y eficiencia operativa.
¿Qué impacto ha tenido su modelo en las comunidades cercanas?
El 98% de nuestros colaboradores viven cerca de las unidades operativas lo que permite que mejoren su calidad de vida al no trasladarse muy lejos para trabajar y de esa manera también, mejorar las comunidades en donde operamos.
Tenemos un convenio con la UNA (Universidad Nacional de Asunción) donde estudiantes de diversas facultades tienen la oportunidad de hacer su extensión universitaria en los asentamientos cercanos a nuestra planta. Esto es un modelo donde todos ganan: la academia, la comunidad y la empresa.

¿Qué rol juega la capacitación del capital humano?
Nuestro departamento de Talento
Humano define un plan anual de capacitación basado en necesidades detectadas, y su cumplimiento está monitoreado por nuestras certificaciones ISO. Ejecutamos el 100% del plan, lo que asegura una mejora constante en capacidades.
¿En
qué consisten sus campañas educativas para consumidores?
Buscamos fomentar el consumo informado de huevos. Cuando iniciamos la campaña, el consumo per cápita estaba en 130 huevos. Hoy día aproximamos los 240 huevos per cápita.
Nuestro Departamento de Nutrición, además de capacitar en las universidades, hacen visitas a médicos, cardiólogos, pediatras y nutricionistas para informar sobre las bondades del producto con evidencia científica. El objetivo es llegar a un consumo de 350-400 huevos per cápita en el largo plazo.
¿El consumidor paraguayo paga más por productos sostenibles?
No, al menos por ahora. Aunque contamos con certificaciones como Sistema B, el precio sigue siendo el principal factor de decisión. Incluso productos con estándares más altos, como el huevo free range, se venden por debajo del precio estándar.
Aun así, apostar por la sostenibilidad es una decisión voluntaria, no una obligación legal. Ser parte de organizaciones como ADEC, el Pacto Global o contar con la certificación B refleja un compromiso real con la ética, los ODS y la gestión con impacto.
Lo hacemos por convicción, sabiendo que el mercado aún no siempre lo reconoce, pero convencidos de que, a largo plazo, la coherencia, transparencia y educación del consumidor marcarán la diferencia.

¿La sostenibilidad mejora su posicionamiento ante socios estratégicos?
Definitivamente. Quienes conocen nuestro modelo no nos reemplazan fácilmente. Aun así, en zonas del interior, el precio pesa más que la sostenibilidad. Por eso, seguimos trabajando en fortalecer nuestra comunicación para que el valor de lo que hacemos sea mejor valorado.

¿Cómo gestionaron la transición generacional?
Hace 7 años diseñamos un protocolo familiar, aún no activado porque la tercera generación aún era muy joven. El proceso llevó 18 meses, con mucho diálogo. El año pasado, hicimos la primera revisión después de ese diseño original, donde acordamos que solo tres miembros (uno por rama familiar) integrarán el directorio, y los demás deberán emprender fuera de la empresa.
Hoy compartimos esta experiencia en congresos de empresas familiares. La profesionalización de la empresa ha sido clave.
¿Qué enseñanzas de Don Antonio Koo siguen vigentes?
El año pasado, a través de un taller, plasmamos la cultura organizacional en un documento. En ese proceso, surgió el legado del fundador que fue transmitido a sus hijos, quienes hoy direccionamos la empresa, y por ende a toda la estructura de la organización. Estos valores son: Integridad, Sostenibilidad y la Excelencia.
Raíces en la tierra, visión en el futuro: La revolución sostenible de Nutrihuevos
DESCÁRGALO EN PDF
¿Cuáles son sus metas en sostenibilidad e innovación para los próximos cinco años?
Nuestro objetivo es consolidar lo que ya hemos sembrado:
Afianzar los tres ejes: Prosperidad, Nutrición y Medio Ambiente.
Construir e implementar la nueva granja, manteniendo altos estándares de bioseguridad.
Integrar inteligencia artificial en toda la operación, desde la producción hasta la sostenibilidad, como parte del ADN empresarial.
Si pudiera resumir el propósito de Nutrihuevos en una sola frase, ¿cuál sería y por qué?
“Con nuestros productos contribuimos a un mundo mejor.”
Ese es el propósito central de nuestra empresa. No se trata solo de producir huevos, sino general valor e impacto en lo económico, social y ambiental.
Este propósito está presente en todas las decisiones que tomamos, desde lo cotidiano a construir un centro de primera infancia para hijos de nuestros colaboradores, a mejorar las comunidades en donde operamos y cuidar el medioambiente.
Es nuestra forma de dejar una huella duradera y coherente con los valores que creemos y promovemos.




